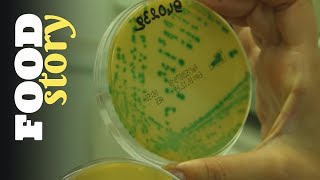
Thumbnail del capítulo

Últimos capítulos

25:54
Terres de Gout : Les routes de la choucroute

24:46
Terres de Gout : La trinité des cassoulets

26:06
Terres de Gout : Escargot de bourgogne montre tes cornes

25:44
Terres de Gout : Le Boeuf Bourguignon

26:42
Terres de Gout : Aligot ou Truffade

25:02
Terre de Gout : La Bouillabaisse à Marseille

51:08
Cuisine : Spécialités Bretonnes

51:27
La Route des Vins - Val de Loire

52:17
La Route des Vins - Sud Ouest

51:32
La Route des Vins - Provence

50:13
La Route des Vins - Languedoc

52:02
La Route des vins - Cote du Rhone

51:41
La Route Des Vins - Champagne

50:12
La Route des Vins - Bourgogne

50:16
La Route des Vins - Bordeaux

52:12
La Route des vins - Beaujolais

51:18
La Route des vins - Alsace

04:06
Homemade mayo with fresh tarragon / Mayonnaise à l'estragon "maison"

02:57
Galette oeuf-pamesan-persil façon involtini / Egg roll with parmigiano and parsley

13:06
Asian style veggie stir-fry / Wok de légumes/ ENGLISH SUBS

04:06
Unpacking my purchases from the market / Retour du Marché

04:28
Recette de galette à la méditérranéenne/ Mediterranean style buckwheat pancake

13:55
Recette de pain "sans pétrir" / Knead-free bread recipe! (english subtitles)

06:02
Confit d'oignons / Onion confit subtitles in English

01:45
Galette bretonne / buckwheat pancake: Variation n°1- The classic egg & cheese

01:50
Cream cheese & sundried tomatoe buckwheat wrap (gluten free)

04:40
Buckwheat nachos & Guacamole / Nachos de sarrasin et guacamole (gluten free)

55:21
La Sologne

58:01
Paysans d'autrefois - documentaire français

52:00
Route des vins - Suisse Romande

51:31
Route des vins - Italie - De la Toscane à l'Adriatique

51:47
Route des vins - La Catalogne

51:58
Route des vins - Savoie - Jura

04:09
Cuisine régionale italienne : La Toscane - Pappardelle au lièvre

02:50
Cuisine régionale italienne : La Toscane - Boeuf au poivre

07:02
Cuisine régionale italienne : La Toscane - Tarte aux herbes de la Lunigiana

04:34
Cuisine régionale italienne : La Toscane - Croutons aux foies de poulet

03:27
Cuisine régionale italienne : La Toscane - Panforte

02:12
Cuisine régionale italienne : La Toscane - Soupe de haricots et de légumes

08:13
Cuisine régionale italienne : La Toscane - Amuse-gueules à la sauce

03:22
Cuisine régionale italienne : La Toscane - Carré de porc à la Florentine

06:58
Cuisine régionale italienne : La Toscane - Haricots à l'étouffée

08:18
Cuisine régionale italienne : La Toscane - Croutons au chou noir

06:39
Cuisine régionale italienne : La Toscane - Amuse-gueules frits

03:31
Cuisine régionale italienne : La Toscane - Soupe de poisson à la mode de Livourne

02:59
Cuisine régionale italienne : La Toscane - Pennes à la buttera

05:10
Cuisine régionale italienne : La Toscane - Viandes cuites à l'étouffée

05:02
Cuisine régionale italienne : La Toscane - Fougasse aux raisins

06:10
Cuisine indienne - Curry de légumes

03:35
Cuisine indienne - Curry de poulet

03:39
Cuisine indienne - Riz aromatique

03:31
Cuisine indienne - Agneau en sauce

03:33
Cuisine indienne - Légumes frits dans une pâte aux pois chiches

05:07
Cuisine indienne - Poulet tikka

03:56
Cuisine indienne - Crème à la cardamome

04:04
Cuisine indienne - Poisson frit dans une pâte aux pois chiches

03:03
Cuisine indienne - Riz et agneau sautés

03:33
Cuisine indienne - Brochette d'agneau

04:43
Cuisine indienne - Poisson tandoori

04:24
Cuisine indienne - Poulet frit

05:26
Cuisine indienne - Poulet tandoori

02:53
Cuisine indienne - Semifredo à la pistache

03:33
Cuisine indienne - Crevettes tandoori

03:13
Cuisine indienne - Sauce à la menthe et sauce concombre

05:13
Cuisine Grecque - Aubergines au four (Mousaka)

03:07
Cuisine Grecque - Roulades de feuilles de vignes

03:32
Cuisine Grecque - Fougasse aux épinards

05:45
Cuisine Grecque - Tomates et poivrons farcis

03:40
Cuisine Grecque - Agneau et pomme de terre au four

03:45
Cuisine Grecque - Boulettes aux courgettes

05:18
Cuisine Grecque - Petites boulettes à la tomate

07:21
Cuisine Grecque - Brochettes de porc avec pain pita (Souvlaki)

02:44
Cuisine Grecque - Beignets frits

03:32
Cuisine Grecque - Poulpe aux petits macaronis

03:02
Cuisine Grecque - Salade rustique

02:52
Cuisine Grecque - Petites fougasses au fromage

05:09
Cuisine Française - Poulet à la Basquaise

06:42
Cuisine Française - Pâté de Campagne

03:34
Cuisine Française - Tarte Tatin

04:03
Cuisine Française - Ratatouille

04:29
Cuisine Française - Quenelles à la Lyonnaise

04:48
Cuisine Française - Filet de Porc, pommes et Calvados

03:08
Cuisine Française - Gratin Dauphinois

04:28
Cuisine Française - Cassoulet

04:39
Cuisine Française - Flamiche Poireaux

04:15
Cuisine Française - Magret de Canard au Poivre Vert

07:47
Cuisine Française - Bouillabaisse

05:19
Cuisine Française - Oeufs Pochés à la Florentine

03:39
Cuisine Française - Mousse au Chocolat

04:29
Cuisine Française - Soupe à l'Oignon

04:18
Cuisine Espagnole - Omelette de pommes de terre

02:31
Cuisine Espagnole - Gambas à la sauce pil pil

04:31
Cuisine Espagnole - Boulettes aux saucissons

03:16
Cuisine Espagnole - Beignets aux poireaux et au jambon

02:16
Cuisine Espagnole - Gambas panées

06:42
Cuisine Espagnole - Paëlla

05:44
Cuisine Espagnole - Pommes de terre à la sauce piquante

04:06
Cuisine Espagnole - Crème catalane

03:32
Cuisine Espagnole - Poulpe à la galicienne

03:39
Cuisine Espagnole - Soupe froide

04:09
Cuisine Espagnole - Oeufs au chorizo

03:14
Cuisine Espagnole - Brochettes de fromage et de pomme

02:49
Cuisine Espagnole - Délices de fromage

03:46
Cuisine Espagnole - Moules au beurre aromatisé

03:06
Cuisine régionale italienne : l'Emilie Romagne - Douceur de noël

06:59
Cuisine régionale italienne : l'Emilie Romagne - Tortellinis émiliens

04:00
Cuisine régionale italienne : l'Emilie Romagne - Douceurs émiliennes

03:59
Cuisine régionale italienne : l'Emilie Romagne - Tagiatelles vertes à l émilienne

05:24
Cuisine régionale italienne : l'Emilie Romagne - Cappellaccis à la courge

06:54
Cuisine régionale italienne : l'Emilie Romagne - Viande de veau farcie

03:48
Cuisine régionale italienne : l'Emilie Romagne - Fèves à la bolognaise

05:02
Cuisine régionale italienne : l'Emilie Romagne - Anolinis à la mode de plaisance

07:27
Cuisine régionale italienne : l'Emilie Romagne - Fagots de parmesan

05:08
Cuisine régionale italienne : l'Emilie Romagne - Tarte aux noix et au miel

05:39
Cuisine régionale italienne : l'Emilie Romagne - Passatellis

03:33
Cuisine régionale italienne : l'Emilie Romagne - Anguille à la mode de comacchio

02:50
Cuisine régionale italienne : l'Emilie Romagne - Boeuf braisé à la mode de plaisance

04:41
Cuisine régionale italienne : l'Emilie Romagne - Paupiettes de veau

05:40
Cuisine Chinoise - 9. Filet de rascasse au gingembre

06:51
Cuisine Chinoise - 15. Raviolis à la viande de porc

05:08
Cuisine Chinoise - 8. Poêlée de fruits caramélisés

04:06
Cuisine Chinoise - 12. Porc à la sauce aigre douce

04:04
Cuisine Chinoise - 13. Soupe aigre-piquante

07:41
Cuisine Chinoise - 11. Rouleaux de printemps

05:11
Cuisine Chinoise - 2. Nouilles de riz aux crevettes

05:05
Cuisine Chinoise - 5. Crevettes sauce citron

02:59
Cuisine Chinoise - 10. Riz Cantonais

05:20
Cuisine Chinoise - 6. Veau au bambou et aux champignons

03:48
Cuisine Chinoise - 14. Haricots verts pimentés

03:36
Cuisine Chinoise - 7. Crevettes panées

05:00
Cuisine Chinoise - 4. Seiches au celeri

04:25
Cuisine Chinoise - 1. Vermicelles de soja à la viande hachée

06:37
Cuisine Chinoise - 3. Poulet aux piments

08:35
Cuisine Brésilienne - 2. (feijoada) Estouffade de viandes et de haricots noirs

03:56
Cuisine Brésilienne - 10. Banane et manioc frit

09:26
Cuisine Brésilienne - 13. Soupe de poisson au lait de coco (Vatapa)

06:31
Cuisine Brésilienne - 9. Poisson à l'étouffée

05:11
Cuisine Brésilienne - 1. farine avec sauce piquante

03:39
Cuisine Brésilienne - 7. Poulet Passarinho

05:53
Cuisine Brésilienne - 8. Crabe en sauce

02:27
Cuisine Brésilienne - 12. CAIPIRINHA

04:43
Cuisine Brésilienne - 11. Boulettes de morue (accras)

03:23
Cuisine Brésilienne - 4. Petits pains au fromage

04:57
Cuisine Brésilienne - 6. Soupe d'écrevisses et de légumes

04:21
Cuisine Brésilienne - 3. Flan de coco (Quindins)

03:13
Cuisine Brésilienne - 5. Salade de poulet (SALPICAO)

52:09
Route des vins - L'argentine

04:45
Cuisine régionale italienne : La Vénétie - Beignets à la vénitienne

03:44
Cuisine régionale italienne : Les Pouilles - Chicorée frisée Racanata

04:15
Cuisine régionale italienne : La Vénétie - Biscuits à la farine de maïs et aux raisins

04:20
Cuisine régionale italienne : Les Pouilles - Aubergines Farcies

04:41
Cuisine régionale italienne : Sardines marinées

04:38
Cuisine régionale italienne : La Vénétie - Pâtes et haricots

03:03
Cuisine régionale italienne : Les Pouilles - Purée de fèves

02:33
Cuisine régionale italienne : Les Pouilles - Agneau

04:10
Cuisine régionale italienne : Les Pouilles - Seiches Farcies

04:29
Cuisine régionale italienne : Les Pouilles - Orecchiette aux brocolis

05:13
Cuisine régionale italienne : La Vénétie - Crème frite à la vénitienne

04:21
Cuisine régionale italienne : La Vénétie - Polenta et petits oiseaux

04:45
Cuisine régionale italienne : Les Pouilles - Pizza aux pommes de terre

05:07
Cuisine régionale italienne : Les Pouilles - Ciceri e tria

02:34
Cuisine régionale italienne : Salade de chicorée à la vicentine

07:14
Cuisine régionale italienne : La Vénétie - Canard farci

04:32
Cuisine régionale italienne : Risotto aux petits pois

03:48
Cuisine régionale italienne : La Vénétie - Couteaux à la cappuccina

03:19
Cuisine régionale italienne : Les Pouilles - Rouget en papillote

04:12
Cuisine régionale italienne : La Vénétie - Morue à la vicentine

03:49
Cuisine régionale italienne : Les Pouilles - Cartellate (Gateaux traditionnels)

02:01
Cuisine régionale italienne : Les Pouilles - Petits poulpes en sauce

06:23
Cuisine régionale italienne : La Vénétie - Poulet à la sauce peverada

06:56
Cuisine régionale italienne : Les Pouilles - Tarte à la ricotta

06:05
Cuisine régionale italienne : Risotto à l'encre de seiche

05:49
Cuisine régionale italienne : Les Pouilles - Chapeau de gendarme (Gateaux traditionnels)

51:42
Route des vins - Paris

03:31
Cuisine régionale italienne : Le Piémont - Beignets aux herbes aromatiques

05:19
Cuisine italienne - Calzone des pouilles

04:32
Cuisine italienne - Pizza capricieuse (Capricciosa)

03:51
Cuisine italienne - Pizza au jambon et aux champignons (Regina)

05:56
Cuisine régionale italienne : Le Piémont - Flan aux asperges avec fondue

08:12
Cuisine régionale italienne : Le Piémont - Roulades de chou

02:55
Cuisine italienne - Fougasse aux olives (Focaccia)

04:15
Cuisine régionale italienne : Le Piémont - Gnocchis au fromage castelmagno

03:46
Cuisine italienne - Fougasse au fromage stracchino (Focaccia)

09:47
Cuisine Italienne : Pâtes - Agnolotti au jus de rôti

06:57
Cuisine régionale italienne - Tiella de moules et de pommes de terre à la mode de Bari

09:17
Cuisine régionale italienne : Le Piémont - Agnolottis piémontais

04:01
Cuisine italienne - Calzone frit au saucisson et à la ricotta

02:58
Cuisine régionale italienne : Le Piémont - Truite à l'escabèche

04:29
Cuisine Italienne : Pâtes - Orecchiette aux brocolis

03:33
Cuisine régionale italienne : Le Piémont - Sauce chaude à l'ail et aux anchois

09:05
Cuisine Italienne : Pâtes - Lasagnes

05:01
Cuisine Italienne : Pâtes - Trofie au pistou

04:23
Cuisine Italienne : Pâtes - Pennes à la sauce piquante (Arrabiata)

05:56
Cuisine italienne - Pizza à la scarole

04:09
Cuisine italienne - Pizza Marguerite (Margherita)

05:22
Cuisine Italienne : Pâtes - Tortellinis à la crème fraîche et au jambon

04:36
Cuisine italienne - Fougasse rustique (Focaccia)

03:55
Cuisine Italienne : Pâtes - Fusillis à la puttanesca

04:06
Cuisine italienne - Pizza aux quatre fromages

07:50
Cuisine régionale italienne : Le Piémont - Friture variée à la piémontaise

03:48
Cuisine régionale italienne : Le Piémont - Flan aux amarettis

04:45
Cuisine italienne - Pizza aux pommes de terre

03:23
Cuisine régionale italienne : Le Piémont - Boeuf braisé au barolo

05:40
Cuisine italienne - Fougasse aux courgettes et aux poivrons (Focaccia)

05:05
Cuisine Italienne : Pâtes - Gnocchis de pomme de terre à la valdôtaine

05:25
Cuisine Italienne : Pâtes - Spaghettis en papillote aux fruits de mer

03:43
Cuisine régionale italienne : Le Piémont - Gateau de noisettes

06:37
Cuisine régionale italienne : Le Piémont - Risotto aux truffes

04:37
Cuisine Italienne : Pâtes - Bucatinis à l'amatriciana

06:48
Cuisine italienne - Pizza à la mode de parme (Parmigiana)

04:45
Cuisine Italienne : Pâtes - Tagliatelle aux cèpes

02:57
Cuisine Italienne : Pâtes - Spaghettis aux palourdes (Alle vongole)

03:46
Cuisine Italienne : Pâtes - Pennes aux artichauts

03:50
Cuisine Italienne : Pâtes - Spaghettis à la carbonara

04:12
Cuisine Italienne : Pâtes - Farfalles au speck aux courgettes et au safran

03:22
Cuisine régionale italienne : Le Piémont - Salade de viande à la mode d'alba

05:07
Cuisine régionale italienne : Le Piémont - Civet de lapin avec polenta

03:50
Cuisine italienne - Piadine romagnole

02:54
Cuisine : le poisson - Queues de crevettes aux courgettes et safran

03:00
Cuisine : le poisson - Loup de mer au gros sel

02:47
Cuisine : le poisson - Poulpes musqués au court bouillon

03:54
Cuisine : le poisson - Calamars à la romaine

04:13
Cuisine : le poisson - Poulpe aux pommes de terre et aux olives

04:10
Cuisine : le poisson - Seiches farcies

03:09
Cuisine : le poisson - Perche en croute parfumée

03:29
Cuisine : le poisson - Espadon à la livournaise

02:38
Cuisine : le poisson - Moules au poivre

04:12
Cuisine : le poisson - Morue à la vicentine

03:20
Cuisine : le poisson - Rougets en papillote

03:49
Cuisine : le poisson - Friture variée

04:14
Cuisine : le poisson - Sardines farcies

02:58
Cuisine : le poisson - Thon à la catanaise

06:37
Cuisine : la viande - Boeuf braisé au barolo (vin rouge)

05:21
Cuisine : la viande - Lapin à la mode d'ischia

03:18
Cuisine : la viande - Saltimbocca à la romaine

05:31
Cuisine : la viande - Agneau de lait à la romaine

03:55
Cuisine : la viande - Carré de porc à la florentine

07:42
Cuisine : la viande - Roulade de dinde

03:03
Cuisine : la viande - Escalopes au marsala

06:39
Cuisine : la viande - Poulet chasseur

07:31
Cuisine : la viande - Pintade et champignons au four

02:17
Cuisine : la viande - Filet de boeuf rossini

04:23
Cuisine : la viande - Filet de boeuf aux artichauts

08:06
Cuisine : la viande - Rôti de veau au lait

04:22
Cuisine Française - Bavarois aux Framboises

03:04
Cuisine : Le Chocolat - Flan au gianduja

04:33
Cuisine : Le Chocolat - Saucisson au chocolat

05:53
Cuisine : Le Chocolat - Tagliatelles au cacao et aux cèpes

07:57
Cuisine : Le Chocolat - Douceur aux poires et à la ganache

04:22
Cuisine : Le Chocolat - Corbeilles de crème ganache à la menthe

04:45
Cuisine : Le Chocolat - Mi-cuit au muscat

06:06
Cuisine : Le Chocolat - Mole de guajolote

02:41
Cuisine : Le Chocolat - Chocolat viennois

06:52
Cuisine Marocaine - Briwat (délice du Maroc)

05:47
Cuisine Marocaine - Chorba (soupe de tomate et de legumes)

02:55
Cuisine Marocaine - Shai bi Naanaa (the vert à la menthe)

04:27
Cuisine Marocaine - Zaalouk (salade d'aubergines)

03:39
Cuisine Marocaine - Khizou Bilimoun (salade de carottes et d oranges)

05:38
Cuisine Marocaine - Kefta del Bid (petites boulettes aux oeufs)

11:44
Cuisine Marocaine - Bastila (paupiette à la viande et aux amandes)

06:09
Cuisine Marocaine - Sardine fi Ferran (sardines au four pommes de terre et aux tomates)

03:25
Cuisine Marocaine - Tajine de boeuf aux prunes

05:00
Cuisine Mexicaine - Cocada con Pina (cocada avec ananas)

04:49
Cuisine Mexicaine - Arroz con Leche (riz au lait)

06:40
Cuisine Mexicaine - Arroz à la Mexicana (riz à la mexicaine)

06:12
Cuisine Mexicaine - Chiles en escabeche rellenos de Atun (poivrons en saumure farcis au thon)

07:46
Cuisine Mexicaine - Chimichanga rellena de Picadillo (chimchanga fourré de picadillo)

04:31
Cuisine : Les desserts - Baba napoletano - baba napolitain

06:27
Cuisine : Les desserts - Semifreddo au sabayon

08:19
Cuisine : Les desserts - Cassate sicilienne

03:19
Cuisine : Les desserts - Pêches au chocolat

04:58
Cuisine : Les desserts - Tarte à la ricotta

03:23
Cuisine : Les desserts - Gateau à base de farine de châtaignes

03:22
Cuisine Mexicaine - Sauce mexicaine

06:05
Cuisine Mexicaine - Soupe aztèque

04:42
Cuisine Mexicaine - Haricots rancheros

03:11
Cuisine Mexicaine - Quesadillas

06:16
Cuisine Mexicaine - Haricots frits

05:05
Cuisine Mexicaine - Enchiladas rouges

04:16
Cuisine Mexicaine - Guacamole (guacamol)

06:17
Cuisine Mexicaine - Salade césar aux crevettes

05:50
Cuisine Mexicaine - Filet à la mexicaine

08:06
Cuisine Mexicaine - Crêpes de fleurs de courgette à la sauce poblana

07:15
Cuisine Mexicaine - Morue à la veracruzana

02:48
Cuisine Marocaine - Kahwa (café arabe)

04:53
Cuisine Marocaine - Gamila (poilée de legumes)

06:20
Cuisine Marocaine - Taboulé (salade froide de couscous)

05:51
Cuisine Marocaine - Brochettes d'agneau avec salade marocaine

03:02
Cuisine Marocaine - Hummus (crème de pois chiche)

04:58
Cuisine Marocaine - Couscous au boeuf et aux legumes

05:30
Cuisine : Le Chocolat - Bavarois aux trois chocolats

06:20
Cuisine : Le Chocolat - Cheese cake bicolore

03:53
Cuisine : Le Chocolat - Gateau au chocolat et aux figues

05:02
Cuisine : Le Chocolat - Muffins aux pistaches

05:17
Cuisine : Le Chocolat - Soufflé glacé à l'écorce d'orange

02:58
Cuisine : Le Chocolat - Truffes au chocolat

04:32
Cuisine : Le Chocolat - Kouglof au gingembre

03:53
Cuisine : Les desserts - Tarte aux amandes

04:35
Cuisine : Les desserts - Cannoli alla siciliana - cannolis à la sicilienne

09:06
Cuisine : Les desserts - Strudel aux pommes

05:05
Cuisine : Les desserts - Dôme gourmand

07:53
Cuisine : Les desserts - Tarte au blé à la ricotta et aux fruits confits ( pastiera napolitaine)

07:35
Cuisine : Les desserts - Douceur à base de génoise, crème et liqueur

03:44
Cuisine : les risottos - Risotto au barolo

04:01
Cuisine : les risottos - Risotto à la chicorée et à la saucisse

04:32
Cuisine : les risottos - Risotto aux petits pois

03:57
Cuisine : les risottos - Soupe au riz et au chou frisé

04:14
Cuisine : les risottos - Salade de riz

05:12
Cuisine : les risottos - Risotto aux cèpes

06:01
Cuisine : les risottos - Risotto aux artichauts

03:07
Cuisine : les risottos - Risotto au champagne

05:09
Cuisine : les risottos - Risotto à la courge

03:35
Cuisine : les risottos - Risotto aux fraises

04:51
Cuisine : les risottos - Risotto aux asperges

02:50
Cuisine : les risottos - Risotto aux truffes

03:59
Cuisine : les risottos - Risotto à la mode de parme

06:08
Cuisine Thaïlandaise - Brochettes de poulet à la sauce aux arachides (SATAY)

02:46
Cuisine Thaïlandaise - Loup de mer (bar) aux trois parfums (PLA SAM ROD)

03:38
Cuisine Thaïlandaise - Curry panang au boeuf (GENG PANANG NEUA)

03:05
Cuisine Thaïlandaise - Crevettes au piment et au jus de lime

03:33
Cuisine Thaïlandaise - Salade épicée aux fruits de mer (YUM THALAY)

04:17
Cuisine Thaïlandaise - Crevettes piquantes sautées au basilic (PAD KRA PRAW GUNG)

03:47
Cuisine Thaïlandaise - Curry vert de poulet (GENG GWIO WARN KAI)

03:17
Cuisine Thaïlandaise - Soupe de poulet au lait de coco (TOM KHA KAI)

03:44
Cuisine Thaïlandaise - Feuilles de riz accompagnées de porc et de brocolis (Pad See Ew)

08:16
Cuisine Thaïlandaise - Raviolis aux crevettes sauce aigre douce (GUNG PHA HOM)

05:40
Cuisine Thaïlandaise - Riz à l'ananas (KAO PAD SAB PA ROD)

02:52
Cuisine Thaïlandaise - Banane au lait de coco (KLUAI BUAT CHI)

02:49
Cuisine Thaïlandaise - Soupe piquante aux champignons et aux crevettes (TOM YAM GUNG)

03:25
Cuisine Thaïlandaise - Gélatine au lait de coco et au café (WUN GATI CAFE)

51:56
Route des Vins - Californie du Sud

52:10
Route des Vins - Californie du nord

25:59
24h en saveurs - Au pays de Forcalquier

27:13
24h en saveurs - Annecy ou la Venise des Alpes

25:31
24h en saveurs - Du côté de Condrieu

25:44
24h en saveurs - Sète au fil de l'eau

27:02
24h en saveurs - Cahors terre de plaisir

51:32
Route des Vins - Espagne - Andalousie

51:16
Route des Vins - Allemagne, De la Moselle au Rhin

50:52
Route des Vins - La Corse

51:34
Route des Vins - Espagne - Le Rioja

52:00
Route des Vins - Italie - Des Alpes aux Apennins

51:44
Route des Vins - Le Chili

25:51
La route des Vins - Castille, La Manche

25:55
Terre de Goût - Le Couscous

25:56
Terres de goût - Confit en Gascogne

25:35
Terre de Goût - Moules Frites

25:52
Terre de Goût - Une matelote sur le Rhin

07:44
Entomophages : La consommation d'insectes - Reportage France 3

27:16
Cuisine exotique : voyage dans nos assiettes - Reportage

30:03
Gastronomie : Les bons petits produits d'internet - Documentaire 2016

01:22:57
GASTRONOMIE : la nouvelle passion des français

28:36
Cosca cook (Akhenaton) : Faf Larage et son carri de poulet

27:43
Cosca cook (Akhenaton) : Anne De Petrini et sa blanquette de veau aux coquillettes

31:06
Cosca cook (Akhenaton) : Bouga et son escalope à la Mozzarella

27:25
Cosca cook (Akhenaton) : Gabrielle Lazure

28:17
Cosca cook (Akhenaton) : Jamel Debouzze et son jarret au miel et aux petits légumes

12:54
Les meilleurs bouchers de France 🇫🇷 Documentaire

13:43
Restaurant : Le retour de la viande de cheval - Documentaire

24:29
la guerre des cocottes : Staub, Le Creuset

51:52
Saveurs d'outre mer : La martinique une ile en héritage

52:20
Saveurs d'outre mer : la Guyane une terre entre deux eaux

54:35
Le business des stars de la toque

17:08
Reportage : Les restaurants Mac Donalds

28:14
Nous raconte-t-on des salades ?

14:23
Pâques, les artistes du chocolat

07:01
Un repas de Noël gastronomique pour trois fois rien !

07:12
Repas de fête : Comment se régaler sans complexe ?

07:31
Défi : un repas de Noël pour moins de 10 euros par personne !

06:22
Que valent les restos routiers ?

30:13
Le chocolat, de la fève de cacao jusqu'au chocolatier

27:52
Le Fooding : les sorciers de la cuisine

06:19
Cream Cheese : Découvrez la nouvelle star de nos frigos

26:29
Crêpes, Un incroyable business

28:13
Mon soda chez moi : la révolution des bulles (Sodastream)

06:37
Cocotte-minute : Les nouvelles methodes de cuisson

06:18
l'Oie de Toulouse - Documentaire

06:35
Bocuse d’or : elle est la première femme à défier les hommes (reportage)

07:24
La Coupe du monde des sandwichs

06:48
Croquettes : elles redeviennent tendance

03:02
Johnny Hallyday dans le meilleur Burger de L.A

52:01
La route des Vins - Italie des îles

51:29
La route des Vins - Du sud à Madère

52:13
La route des Vins - La Tunisie

51:59
La route des Vins - La Georgie

51:12
La route des Vins - Porto à Lisbonne

52:01
La route des Vins - La Crimée et la Moldavie

51:40
La route des Vins - Le Japon

49:51
La route des Vins - La Grèce

52:06
La route des Vins - Afrique du Sud

51:41
La route des Vins - Liban

06:44
Patisserie : L'agneau de Pâques revisité

06:19
Alimentation : Konjac, le nouvel allié minceur

06:43
Cuisiner les oeufs pochés (reportage)

06:14
Cuisine : Les bonnes recettes pour un pique-nique

07:04
Glace française, américaine ou italienne : comment choisir ?

07:04
Glace pilée, glaçon, glace carbonique : des recettes rafraîchissante

06:46
Cuisine au foin : redécouvrez les étonnantes saveurs d’autrefois

06:47
Record : La plus grande tarte aux fraises du monde !

07:06
Fromage et dessert au BBQ

06:21
Boisson : Tout sur le jus de fruit

07:13
Reportage : Sardines de luxe à prix très cher !

05:15
Ces aliments qui donnent bonne mine (reportage)

04:45
Lait d'amande, de soja... cuisinez sans lait de vache

05:36
Equiper sa cuisine comme un pro pour trois fois rien

07:19
Brasserie, auvergnat : Ma région me suit partout (reportage)

06:46
Tuto : Cours pour faire des sandwichs chics !

06:20
Comment remplacer le sucre dans vos recettes ?

06:03
Maquereaux, sardines, harengs : tout sur les poissons l’été !

07:23
Le Pan Bagnat niçois !

07:00
Cuisine et Barbecue

06:37
Les algues : à la carte des plus grands chefs

05:29
La cuisine monochrome

07:08
Quel type de cuisson pour la santé ?

01:51:01
L'histoire des grands vins de bordeaux

05:18
Recette : biscuits maison

06:35
Succès : la cuisine française à seoul

06:11
La saison des champignons est ouverte !

07:00
Cuisine, comment se simplifier la vie ?

07:08
Cuisine brésilienne

08:10
Le concours des mini chefs

04:41
Cramberry : le fruit qui soigne tout !

04:15
Les eaux aromatisées

05:35
Les nouveaux tarama

07:25
Le boom des nouveaux appareils de cuisson

07:18
La cuisine épicée est-elle vraiment bonne pour la santé ?

05:40
Les nems à toutes les sauces

07:01
Cuisine : Régalez-vous des champignons sans vous ruiner !

07:09
Le Hamburger à nouveau à la mode !

05:22
Poêles, ustensiles : la céramique fait des miracles

05:05
Cookies : sucrés ou salés, ils vont vous étonner

05:52
Enquête sur la vanille

06:08
Les margarines sont-elles bonnes pour la santé ?

06:49
Les tapas

06:03
Les biscuits faits maison

07:12
Régalez toute la famille avec vos empluchures !

06:39
Sushis maison : c'est pas si compliqué

07:50
Qui sera le meilleur crépier ?

06:22
Les vertues des Omégas 3 ?

08:03
Le concours de cuisine moyenâgeuse

06:54
Comment préparer les poireaux

06:57
Découvrez la Cucina Povera, la cuisine la plus economique

07:46
Comment récupérer ses plats ratés

06:56
Des énormes légumes

07:22
Un repas de Noël équilibré

06:56
Cuisine : la revanche de la paupiette

07:25
Le grand retour de la chicorée en pâtissierie

04:38
Flambage : donnez de nouvelles saveurs à vos plats !

07:29
Le retour des sucettes

07:01
Tout sur le décafeiné

04:17
La nouvelle coqueluche des gastronomes : Le caviar d'escargot

06:10
Fast food et gastronomie, le nouveau concept

06:07
L'engouement des viandes exotiques

05:12
Les oleagineux

06:35
Il mange des insectes

06:33
Fruits et légumes : C'est bon ?

05:55
Ils investissent nos terroirs

06:31
Un menu spécial crise

05:20
Gadjets pour la cuisine

06:07
Les patates du futur

06:15
Les salades, on en mange aussi l'hiver !

06:16
La folie des yaourts

06:45
Les frites sont-elles bonnes pour la santé ?

06:57
Comment acheter des produits frais à des prix abordables ?

06:31
La mode des fours à pain

04:09
La Space Food

06:56
Les cours de cuisine sur internet

07:01
Qui gagneras la Mini-toque ?

06:15
La pasta

07:11
Sous la toque d'un chef

06:35
La folie des fruits et legumes en sachet

12:48
Le record du plus grand gratin dauphinois

07:09
Les recettes des papas divorcés

51:45
L'absinthe était bonne - documentaire

13:06
Thierry Marx, un chef en prison

30:05
Pompier et chef cuisinier !

06:38
Recettes de pâtes originales

07:31
Le Kale

06:38
Poissons, légumes : découvrez les autres steaks !

05:45
Enquête sur les biscuits petit déjeuner

04:51
La MODE des paniers bio

52:23
Tout pour mon potager - Documentaire

06:16
Les fruits et légumes en sachet

06:43
Les nouveaux sandwichs

01:06:55
Empaquetarlo: un fenómeno común en los supermercados

12:57
Le grand retour de la brioche

30:08
Le Safran - Documentaire

12:14
Le fabuleux destin de la mousse au chocolat

35:31
Restaurants chinois : les coulisses des cuisines - DOC CHOC

06:34
Le Hot Dog : plus fort que le Burger !

06:46
Au diner, faites-vous mousser !

06:43
Les gougères

06:12
Des desserts, du plat à l'entrée !

06:42
Faire soi-même ses chouquettes

07:46
Le parcours d'une côte de boeuf, de l'élevage à l'assiette

06:22
Mauvaises herbes : mangez les !

07:02
Cuisiner ensemble viande et poisson

07:19
Mangez vos épluchures !

05:55
Les bienfaits de la cuisine sautée

06:06
Les secrets de la cuisine au bitume !

06:30
Enquête sur les pizzas de supermarché

07:09
Champignons : les astuces pour se régaler sans se ruiner

05:51
Le Barbecue, c'est aussi bon en hiver

05:58
Gratin, soupe ou poêlée: osez la salade cuite!

05:21
Soufflés : les secrets pour les réussir à coup sûr

06:18
César salade, l'impératrice des salades

39:21
C'est trop bon avec Franck Dubosq

15:08
Les FoodTrucks

27:41
La Tomate, comme on l'aime ?

51:24
SUSHIS : les Recettes d'un Succès

06:48
La menthe et les secrets pour notre quotidien

16:19
Champion de pizzas

17:09
Claude Troisgros, une success story au Brésil

20:16
Le top des chefs

25:35
Enquête sur les usines à tomates

26:10
Fast Food : Restauration rapide : Alerte en cuisines !

48:10
Le Sel : Tous accros !

50:29
Le steak haché

02:01
Vrai-Faux : La Vérité sur les Huitres

07:10
Je triche en cuisine et j'assume

36:00
Chips, une passion dévorante

06:38
Poissons, légumes, découvrez les autres steaks

04:32
Légumes, viandes et desserts se mangent en cône

06:16
Ils se régalent à la cantine

06:30
Que valent vraiment les pizzas de supermarché

06:26
Faut-il bannir le plastique de nos cuisines

04:33
Les déserts alimentaires américains

06:43
Gougères, redécouvrez le chouchou des Bourguignons

08:01
Le kale, le chou qui a la côte

06:12
Choux, éclairs, religieuses - découvrez-les en version salée

05:38
Ils mangent en s'amusant

05:34
Il tente le record du monde du plus grand cornet de frites

05:21
Soufflés, les secrets pour les réussir à coup sûr

05:45
Que valent les biscuits petit-déjeuner

08:19
Offrez un nouveau look à votre cuisine

06:16
Que valent les fruits et légumes en sachet

06:38
Gratins, ragoûts, soupes, cuisinez vos pâtes autrement

07:37
Faire ses courses en ligne, bon plan ou galère

06:13
Vente de légumes à domicile, attention aux arnaques

07:16
Régalez-vous avec des morceaux de viande méconnus

06:41
Un homme teste le régime Dukan

05:58
Gratin, soupe, poêlée, osez la salade cuite

06:42
Simple et pas cher, osez faire vos propres chouquettes

06:38
Ils partent en guerre contre les emballages

06:06
Insolite, la cuisine dans le bitume

05:55
Cuisine sautée, découvrez ses bienfaits

06:37
Cocotte-minute, cuisiner gourmand et sain en un clin d'oeil

07:00
Délicieux et économique, redécouvrez le poulet rôti

06:48
Faciles à préparer et délicieuses, redécouvrez les croquettes

05:54
Vaisselle à la main ou en machine, le match

06:35
Le boom des restaurants Français en Corée du Sud

06:43
Simple et délicieuse, découvrez la cuisine pochée

06:22
Orties, rumex, plantain, regalez vous avec les mauvaises herbes

06:43
Leurs produits sont servis à la table du Président de la République

06:54
Poireaux, découvrez mille et une façons de vous régaler

06:19
Cream Cheese, la nouvelle star de nos frigos

07:05
Les aliments premiers prix

07:46
Des astuces pour sauver vos plats ratés

06:35
Bocuse d'or, elle est la première femme à défier les hommes

04:29
Rapadura, le nouveau sucre miracle

06:34
Le hot dog va -t-il détrôner le hamburger

23:39
Halloween, les bonbons en folie !

07:00
Avoine que vaut vraiment la plus tendance des céréales

07:29
La folie des sucettes

06:08
Ils distribuent les invendus aux plus démunis

09:16
Les dates de péremption nous poussent-elles au gaspillage

06:57
Des produits frais, pas chers et accessibles

06:47
Ils vont préparer la plus grande tarte aux fraises du monde

06:17
Cuisine, le plein d'astuces pour gagner de la place

04:43
Beauté, cuisine, ils ne jurent que par l'eau minérale

06:39
Sushis maison, c'est pas si compliqué

06:22
Que valent exactement les Omega 3

09:21
Faut-il bannir le plastique de nos cuisines

06:44
Fruits et légumes, comment être sûr de bien les laver

07:01
Produits décaféinés, que valent-ils exactement

07:03
Des menus gourmands pour diabétiques

07:40
Les coupe-faim sont-ils tous dangereux

05:22
Cuisine, le boom de la céramique

04:41
Carafes filtrantes, faut-il s'en méfier

07:19
Régalez toute la famille avec des épluchures

06:15
Salades, parfaites aussi l'hiver

04:51
Les paniers bio

04:17
Le caviar d'escargot

04:15
Les eaux aromatisées

07:00
La cuisine assistée

07:18
Cuisine épicée, faut-il s'en méfier

12:30
Etonnant, ils veulent réaliser le plus grand gratin du monde

07:09
Champignons, les astuces pour se régaler sans dépenser

07:51
Les régimes à la mode sont-ils efficaces

06:22
Que valent les restos routiers

07:08
La cuisine brésilienne, de la samba dans nos assiettes

06:48
Economique et pleine de saveurs, redécouvrez la cuisine espagnole

05:35
Tarama, découvrez d'incroyables recettes

06:20
Le cranberry, fruit miracle ou pas

05:52
Quelle vanille dans nos produits

06:24
Les nouvelles méthodes détox

04:26
L'ortie : qui s'y frotte, s'y pique

06:10
Les gaufres, petit plaisir d'hiver

06:13
Bien manger au ski, est-ce possible ?

40:01
C'est trop bon ! Daniela Lumbroso reçoit Dave

08:10
Découvrez les Bonnes Soupes de l'Hiver

05:54
Le Kiwi : un atout pour l'hiver

06:12
Cet hiver, au coin du feu, mangez suisse

07:52
Cet hiver, faut-il succomber à la mode vitaminique ?

09:07
La bûche de Noël revisitée

01:15:33
Gastronomie de Noël

07:14
Que valent les produits des marchés de Noël ?

07:01
Un repas de Noël pour moins de 10 euros par personne

07:22
Un repas de fêtes basses calories

09:28
Marché de Noël : cadeaux, friandises et arnaques !

39:44
Halles de Lyon, au paradis des gourmands

07:10
Découvrez les 13 desserts de Noël

07:53
La coquille Saint-Jacques : comment la choisir et la cuisinier

06:12
Les huîtres

01:15:33
Gastronomie de Noel - Tous sur les produits stars de nos fêtes !

06:52
Produits de fête low cost, que valent-ils vraiment ?

06:28
L'oignon à la fête

08:07
La cuisine anti-gaspi, économique et écologique

07:02
Je dois cuisiner pour 10 personnes : comment m'en sortir

03:34
Chef étoilé en altitude

06:06
La folie des mini légumes

07:57
Fatigué des frites et purées ? Voici comment renouveler la patate !

08:37
Il teste des restaurants et des hôtels pour que vous passiez de bonnes vacances

28:14
Nous raconte-t-on des salades

13:46
La guerre des baguettes

05:05
Le boom du fait maison

06:06
Les apéritifs

05:52
Lycées hôteliers : de la cuisine à moindre prix

05:58
Nuggets, cordons bleus : qu'y a-t-il vraiment dedans ?

06:44
Faire des délices avec des produits de supermarchés
05:43
Congélation, décongélation : mode d'emploi

07:09
Comment faire les sushis soi-même ?

02:21
Vrai-Faux:La Vérité sur les Produits Surgelés

05:52
Le fromage blanc est-il un véritable allié minceur

05:53
Les bienfaits du citron

07:35
Le magret de canard : découvrez le plat préféré des français, tradi ou trendy?

07:36
Labels bio : attention arnaques

06:06
Les céréales qui montent

07:37
Les épices

06:06
Les aliments enrichis sont-ils utiles

06:08
Peut-on croire aux margarines sante

06:31
Le grand retour du four à pain

07:24
Que valent les nouveaux appareils de cuisson

06:28
Nouveau des restaurants viennent à vous

06:45
Peut-on manger des frites

06:35
Que valent les fruits et légumes en sachets

06:30
Produits halal, sont-ils moins chers et meilleurs

05:29
Tout est bon dans le cochon

07:23
Café, dosettes vs vrac

13:43
Viande, la revanche du cheval

06:56
Le cooksurfing

07:43
Régalez-vous avec un simple poulet rôti !

07:48
On joue à "un dîner presque parfait" entre amis

06:07
Le hamburger

06:18
Salade césar, les secrets de la plus gourmande des salades

06:56
Cuisine, la revanche de la paupiette

06:19
Konjac, le nouvel allié minceur

02:08
Vrai-Faux:Comment bien Ranger son Frigo?

03:11
Poulets en batterie

06:59
Les crêpes, simples, économiques, et très lucratives

07:50
Le concours du meilleur crêpier

04:41
Ce boucher transforme de la viande - Documentaire

12:40
Portrait:Quels sont les Secrets pour Concilier leur Vie de Chef et de Maman ?

08:47
La face cachée des fast-foods

08:17
Régime fractionné, peut-on maigrir en grignotant

06:41
Marinade : l'ingrédient secret des plats réussis

04:34
Quand tu cuisines gras de chez gras

07:46
La folie des restaurants français au Japon

05:48
L'oreiller de la belle meunière

04:34
Terrines : Stop à l'arnaque à l'étiquette !!

04:30
Et vous, votre charcutier il continue a faire lui-même ?

02:01
Blind test pâté de campagne

51:31
La route des vins : La Chine

06:03
Je fais mes biscuits

02:12
Pour un repas équilibré

42:01
Produits Lights : la vérité sur les faux sucres

06:42
Un Bucket sauce ASTICOT ! SVP - Frites coca ???

03:02
Recette simple de pâtes à la Bolognaise

06:44
Agneau : régalez-vous en le cuisinant autrement

02:45
Le porc noir de Bigorre

04:31
Le sang de la terre

03:14
Gastronomie et traditions

51:33
Des insectes dans nos assiettes

03:44
Petit cours de cuisine avec Jean-Michel Bannwart

05:46
Les Colas régionaux

07:09
Poisson, herbes, tofu découvrez les nouveaux hamburgers

07:09
Chocolats belges : attention aux arnaques !

07:21
Régalez-vous avec les antipasti !

06:37
Fruits et légumes en conserve : que valent-ils vraiment

07:33
La cuisine fait son show

07:13
Teurgoule, Kouign Amann : c'est calorique mais tellement bon

06:19
Les arts de la table

05:52
Les biscuits sont-ils bons pour la santé

07:41
Les cheesecakes

06:52
Kouign amann, far, gâteau breton, découvrez les pâtisserie plaisir

07:01
Le kebab est-il bon pour notre santé ?

05:35
Les tisanes

06:46
Cuisine au foin, redécouvrez les étonnantes saveurs d'autrefois

05:05
Des cookies, de l'entrée au dessert

13:06
Thierry Marx un chef en Prison

07:54
Comment choisir son lait

07:25
La viande charolaise : la meilleure de France

06:01
Choisir son fromage

07:23
Pan Bagnat, la plus gourmande des spécialités niçoises

06:43
Le Sandwich

10:10
Au Lait, à l'Ancienne, Aromatisées : Qu'y a-t-il dans les Purées Déshydratées

06:04
Les herbes aromatiques

03:09
L'élevage des porcs que l'on retrouve dans nos terrines

08:03
Cuisson au foin, vessie de porc, légumes oubliés, découvrez la cuisine du Moyen-âge

07:25
La chicorée, nouveau chouchou des chefs et des pâtissiers

04:31
Boucher des stars

06:43
Qui sera le champion de la soupe

08:50
Cuisine : La Charcuterie Italienne est-elle la Meilleure du Monde ?

07:50
Peut-on manger avec 0% de matière grasse ?

03:51
Le pâté, c'est tendance

07:53
La sauce piquante : aïe, aïe, aïe caramba !

02:58
Les terrines de Gilles Vérot

05:36
Boulanger / Épicier / Imprimeur

06:51
Quand les enfants cuisinent

07:01
Concours des Mini Toques

07:24
Ils rêvent de gagner la coupe du monde des sandwichs

06:46
Le sandwich superstar

07:42
Cuisine : Viennoiseries, apprenez à les faire vous-mêmes !

04:33
Les secrets d'un chocolat chaud réussi

05:24
Combo Police + Hygiène

06:54
Quand c'est beau c'est bon

07:11
Quand des inconnus prennent la place des chefs

06:40
Osez l'english breakfast

06:40
Les secrets d'une bonne viennoiserie

06:39
Choisir la casserole idéale

05:43
Mini électroménager

08:03
Ils inventent les nouveaux produits du terroir

07:23
Je veux être boucher

06:36
Plats cuisinés de régime que valent-ils vraiment

06:12
Vinaigre balsamique : comment le choisir sans se tromper

06:58
Cuisinez malin avec peu de moyen

05:59
Quel repas me permet de bien dormir

06:14
Apprenez à faire du brunch le repas le plus sain de la semaine !

06:45
Champagne: comment reconnaitre le vrai du faux

07:21
Carpaccio, tartares : osez la cuisine crue

06:38
Pourquoi la nourriture japonaise nous plaît-elle tant ?

06:54
Le boom de la cuisine thaï

05:56
Les citrons

07:25
La soupe de poissons fait débat

05:22
Les sucres: Comment les choisir?

07:22
Bien choisir sa salade

06:24
La cuisine indienne

06:45
Champagne: comment reconnaître le vrai du faux

10:39
Millonario gracias al kebab

06:36
Plats cuisinés de régime que valent-ils vraiment ?

07:27
Le fast-food végétarien débarque en France

07:10
Machine à pain : en a-t-on vraiment besoin ?

07:14
Cocktails carnivores

04:51
Mettez vous au jus d'herbe

06:16
Un restaurant pour redonner vie au village

06:12
Rendre sa cuisine ergonomique

07:37
J'ai perdu le goût

03:56
Le tilapia : la star de la gastronomie Africaine

05:59
Le Miel Urbain

05:56
LE TINY TEA (Le thé qui fais maigrir)

06:13
Manger low-cost

06:51
LES FROMAGES QUI PUENT

06:26
LA FOIRE AUX VINS

07:17
La clémentine : ne la croquez pas, cuisinez la !

06:43
Le taboulé dans tous ses états

04:07
Griller un poulet dans un lavabo

05:17
Les glaces italiennes sont-elles les meilleures du monde

04:37
Fumer un saumon dans une boite à chaussures

07:11
TOULOUSE, FRANCFORT, MONTBÉLIARD : On aime toutes les saucisses

05:49
LES TARTINES CE N'EST PAS QUE POUR LE PETIT DÉJEUNER

06:25
ON FARCIT TOUT

06:49
ON AIME TOUS LES HARICOTS

07:09
Que valent les poissons en boîte ?

07:15
100 % SAUCE SOJA

07:11
Nouvelle tendance : Le bar à omelette

06:19
C'est moisi mais c'est bon !

06:25
La charcuterie de la mer !

06:11
Spécialité New-Yorkaise : les CRAGELS

06:09
Que valent les régimes sans gluten ?

02:40
Restaurateur de camping : Un plan en or

06:40
Redécouvrez le chocolat blanc

07:11
Les secrets du Gratin Dauphinois

07:02
100% nuggets

05:06
Supermarchés, les rois du gaspillage

06:38
SAUCES SALADES

06:38
Joue, queue, langue, oreilles : le retour des viandes oubliées

06:05
Marc de café : recyclez-le !

06:57
Paniers garnis : bon plan ou arnaque ?

04:22
Bruno, la légende vivante de Saint-Jean-de-Monts

04:38
Association : Invendus pour démunis

05:30
Ils doivent jeter des tonnes de poissons devenu invendable, c'est la loi !

07:04
Volaille : La viande préférée des français

03:02
L'énorme gâchis alimentaire des hôpitaux

06:42
Les secrets de la frite parfaite

03:45
Comment se procurer une pâte à tartiner de qualité ?

03:04
Elle mange au resto 4 fois par semaine

07:06
Fromage ou dessert, cuisinez-les au barbecue

06:42
Café, thé, chocolat, dégustez- les...glacés

07:03
Glace italienne, américaine ou française, le match

06:49
La menthe : les secrets de la plante la plus fraîche de l'été

06:28
La nourriture de plage

04:44
La paëlla

06:28
La glace, la star de l'été

05:34
Le mensonge des industriels sur la pâte à tartiner

04:42
L'arnaque des grands guides de la restauration

05:34
La malédiction de la manouille

03:14
Nutella, ces gros menteurs

03:11
Bertrand, le roi de la frite

06:40
La mozzarella comme vous ne l'avez jamais vue

04:28
Pâte à tartiner : Quand BIO ne veut pas dire "sans huile de palme"

04:02
Dans cette famille l'agneau rôti c'est tout un art

07:25
Le saucisson, secrets de fabrication

04:24
Les noisettes made in France

07:19
KFC, histoire d'un succès

05:39
Le plus gros mangeur de livarot, c'est lui !

02:16
La vérité sur les calories

05:01
Il doit cuisiner 750 kg de macaronades pour le déjeuner

07:34
Mettre son enfant au régime, bonne ou mauvaise idée ?

07:58
Bien manger à la cantine, c'est possible !

06:16
Quand le made in région fait recette !

04:49
Cet été, mettez-vous aux soupes froides !

06:07
Comment se procurer des tomates de qualité ?

08:09
La tapenade : l'apéritif de l'été

07:03
Nuggets de cervelle, salade de tétine de vache... à table !

07:21
Que valent les pâtisseries prêtes à servir ?

05:46
Pesticides dans nos assiettes : comment s'en débarrasser ?

07:38
Que valent les préparations pour dessert ?

06:05
Les astuces pour un frigo bien rangé

06:34
La meilleure andouille, c'est la mienne !

06:54
Chorizo : nos idées recettes pour surprendre vos papilles

04:10
Le concours de la meilleure Fallue

07:15
Préparer un repas de fête avec les restes

03:24
La brioche : le pain des pauvres ?

08:18
Croque-monsieur, craquez pour ces recettes surprenantes !

06:21
Les petits suisses vont vous étonner

06:16
Les biscuits diététiques tiennent-ils leurs promesses ?

05:12
Va-t-elle réussir son examen de chef cuisinier ?

04:56
Comment faire des beignets bons et pas gras ?

07:10
Restaurants de plage, gare aux arnaques

04:37
Connaissez-vous la cuisine cristalline ?

09:16
Arpège, dans les coulisses du restaurant étoilé

09:33
Quand manger sain vire à l'obsession

03:28
Maison Blanche : un restaurant haut de gamme nous ouvre ses portes

08:04
Comment sont fabriqués les steaks hachés ?

06:13
Le hot dog sous toutes ses formes

07:04
Sauce faite maison VS industrielle : le match !

06:54
La charcuterie light, se faire plaisir sans complexer

06:32
Comment réussir les meilleurs oeufs mayo

07:07
Manger gras rend heureux !

06:46
Nos cuisines sont-elles vraiment propres ?

06:11
Découvrez la cuisine aux arbres !

06:43
Découvrez les confiseries 100% naturelles

05:38
Les alternatives saines aux chips

05:33
Cuisinez la chapelure pour des plats savoureux

06:46
Stop à la malbouffe des menus enfants

06:13
Délicieuse, diététique et peu chère : mangez de la raie !

06:36
Resto insolite : à bord du Bustronome à Paris

05:24
La bouillabaisse à 15€ VS à 47€

07:40
Produits exotiques de supermarché, que valent-ils ?

05:36
Adieu la bouteille, les canettes de vin débarquent en France !

06:09
Nos astuces pour cuisiner la viande hachée

03:06
Dans les coulisses des cuisines des grands hôtels

06:55
Craquez pour la crevette

05:37
Energisant, sain et naturel, découvrez le maté

13:17
Bouchers contre vegans, guerre ouverte !

06:57
Equilibrée et savoureuse, mettez-vous à la cuisine marocaine !

06:45
Petits et grands, amusez-vous avec la cuisine surprise !

07:38
Je prépare le dîner en 15 min chrono !

07:40
Cuisinez vous-mêmes les gâteaux préférés de vos enfants

05:44
Vous saurez tout sur le basilic

06:52
Régalez-vous avec la cuisine sicilienne

03:07
Menu des restaurants, attention aux arnaques

05:49
La fraise de Plougastel, fierté de la Bretagne

07:04
Apprenez à cuisiner la moule !

06:43
La cuisine XXL : attention, plats géants !

31:09
Bio, quand les cantines font leur révolution

04:34
Les desserts à pousser, c'est encore meilleur !

09:09
La viande est-elle devenue un produit de luxe ?

25:40
Pommes, pesticides et santé, les vérités qui dérangent

06:52
Le meilleur gâteau au chocolat, c'est le mien !

49:57
Pâtes à tartiner, secrets de fabrication

06:32
Le croque-monsieur, un indémodable revisité

06:30
Redécouvrir les desserts de nos grands-mères

06:20
Insolite : il grille un cœur de veau sur les rails du métro

26:46
Le saucisson, de la porcherie à l'assiette

06:57
Cuisinez vous-mêmes les barres chocolatées !

01:27:59
Sándwich de jamón y mantequilla, el eterno protagonista de la pausa para la comida

12:55
Dans les coulisses d'un des meilleurs restaurants au monde

06:06
La pâte d'amande, la reine des friandises

57:56
Rungis, le garde-manger de l'Europe

07:39
Régalez-vous avec les foies !

25:51
Winstubs, au cœur de la tradition alsacienne

07:16
Y a pas à dire, en Auvergne on sait bien manger !

07:14
Faites-vous plaisir avec la fondue japonaise !

01:02:06
Manger sain : l'obsession des régimes "sans"

03:35
Les bouteilles à 100 000€ des Rothschild

06:40
Les recettes méconnues de la cuisine savoyarde

52:31
Plats industriels : que reste-t-il de la gastronomie française ?

06:30
Les cafés de spécialité, secrets d'un produit d'exception

05:59
Bien manger pour bien dormir, ça s'apprend !

44:23
Le championnat du monde de pizza

04:51
Le fonio, la céréale qui a la cote

04:36
Œufs au lait infusés aux épices - Méthode Montignac

53:16
Dans les cuisines de l'Elysée : au service du Palais

05:15
Pimpez vos recettes avec les farines aromatisées !

07:09
Les fromages, mangez-les chauds !

06:43
La banane, cuisinée en dessert, c'est encore meilleur !

51:13
Fraude alimentaire : quand les industriels nous mentent

04:55
Alimentation et santé : ce qu'on nous ne dit pas sur les poulets de batterie

03:44
Il remplace les chips par des insectes

03:10
Supermarchés, des fraudes massives aux fausses promos

04:45
L'histoire de la conserverie bretonne la Belle-Iloise

04:23
Bangkok, dans la peau d'un vendeur d'insectes ambulant

07:38
Thanksgiving, cuisinez LE repas américain !

41:21
Mondial du Pain, qui sera le meilleur boulanger du monde ?

03:43
Sur les marchés, vérifiez bien la balance des primeurs…

03:32
Pour produire moins cher, il installe son usine de sardines au Maroc

03:02
Ce restaurant sert des salades de grillons

04:06
Ces industriels qui trichent sur le poids affiché

03:11
Dans cette brasserie, on vend des sardines millésimées

03:26
Il élève des insectes pour en faire des sucettes

01:23:33
Plats cuisinés, viandes, fast-food : révélations sur l'alimentation pas chère

03:53
L'arnaque des petits formats dans les supermarchés

03:32
Les insectes, la nourriture de demain ?

03:06
Le secret des fabricants pour vendre des sardines bas de gamme

04:03
Un repenti de l'agroalimentaire révèle les secrets des industriels

03:24
La pâtisserie de Noël du Bon Marché

03:49
Son défi, faire aimer la truffe aux Américains

51:30
Restaurants : suivez le guide ?

03:05
L'additif inquiétant utilisé dans les jambons industriels

05:48
Cet entrepreneur veut révolutionner nos assiettes

03:20
La truffe, le business de l'or noir

04:09
L'arnaque du saucisson light

03:10
Saucisson artisanal VS industriel

06:41
Marre des bonbons chimiques ? Faites-les vous-mêmes !

30:20
Dans les coulisses des cuisines des grands chefs

04:09
Voici comment on fabrique un saucisson traditionnel

07:03
Raclette, plancha : on détourne nos appareils ménagers !

03:18
Ils ont inventé le saucisson de poche

06:04
A quoi sert la forme des pâtes ?

03:16
Ils créent des truffes en laboratoire

03:10
Une glace industrielle, c'est moitié air, moitié glace

03:03
Ces marins repèrent les sardines à l'œil nu

03:36
Les recettes secrètes de ces grands cultivateurs de truffes

04:29
Cet industriel fabrique 60 millions de saucissons par an

03:03
Ce chef prépare des œufs brouillés à 175€ !

03:03
Son grand-père lui lègue un terrain rempli de truffes

03:12
Un chef étoilé rencontre un chef de cantine

03:01
Une start up française veut révolutionner les cantines américaines

06:26
Gourmand et pas cher, cuisinez l'os à moelle

42:38
Le cidre, l'art de vivre à la Normande

13:50
La folie des blogs culinaires

03:01
Qui sera le meilleur chef de cantine de France ?

06:07
Astuces : comment ne plus gâcher le pain ?

07:14
Supermarchés VS courses en ligne

07:23
Faut-il se méfier des plats cuisinés ?

01:34:11
Frigos high-tech à prix cassés, que valent-ils vraiment ?

07:50
Les secrets des meilleurs cannelés

08:33
Le sirop d'érable, un trésor venu du Québec !

07:29
Je fais ma propre huile d'olive

06:48
Gâteaux sur mesure : les plus beaux, mais pas les meilleurs !

07:21
La cuisine argentine a conquis les Français

28:13
Je fais mon soda à la maison

06:02
Cuisinez les meilleurs cookies !

06:37
Ils construisent la cuisine de leurs rêves !

06:38
A la découverte de la cuisine des îles

13:46
Hot dog, la star de la junk food

06:45
Les secrets d'un bon bouillon

06:49
Et si on se lançait dans la cuisine à la broche ?

01:13:07
Saveurs provençales, secrets de terroir

06:14
Et vous, vous pratiquez aussi le brunch ?

12:26
Chef étoilé de père en fils

07:02
Dans la peau d'un chef pâtissier

06:46
Quel est le meilleur mode de cuisson ?

13:46
L'éclair, la star des pâtisseries

13:55
Le chocolat français a conquis la Chine

44:06
Gastronomie : la passion française

06:14
Ne jetez plus les os, cuisinez-les !

12:13
Etoiles Michelin, la malédiction

13:22
Norbert de Top Chef, une star aux fourneaux

05:22
Certains sucres sont-ils bons pour la santé ?

03:27
Nourriture sous-vide et microondes, la fin des chefs en cuisine ?

04:13
Infiltration dans une brasserie parisienne

03:06
L'exigence d'un chef 2 étoiles

03:05
Quand on apprend la cuisine industrielle aux futurs chefs

03:55
Un chef nous partage son amour de la bonne cuisine

04:49
Ce restaurateur ne vend que des plats industriels

03:41
Mozzarella di bufala VS mozzarella au lait de vache

03:37
Dans le restaurant le plus cher au monde

04:36
Food Truck 100% Gaufre !

03:04
Les secrets de la mozzarella traditionnelle

03:19
Le meilleur ouvrier de France devenu VRP des industriels

04:19
Dans ce magasin, on vend ce que les autres jettent

05:37
Cette brasserie sert 24/24 & 7/7

03:12
Le danger des plats industriels servis dans les restaurants

03:35
La bubble Waffle, la gaufre qui nous vient d'Asie

03:09
Le scandale de la fausse mozza

52:15
Australie, la route des vins

05:17
Championnat de France de cuisine amateur

03:03
Meert, la gaufre originale de Lille

03:25
La burrata, le fromage italien qui détrône la mozzarella

03:15
L'appli anti gaspi qui révolutionne nos repas

04:56
Comment est fabriquée la mozza haut de gamme de supermarché

04:33
La brigade de ce restaurant livre ses secrets

31:46
Pistache, la guerre de l'or vert

03:42
Quand les politiques s'engagent pour le fait maison

03:13
Du faux sucre génétiquement modifié

03:18
Un supermarché avant l'ouverture, ça ressemble à ça

05:13
Les résultats inquiétants des études sur l'aspartame

02:44
Cette plante est cultivée en Chine, mais aucun Chinois n'en mange

03:02
Les industriels remplacent l'aspartame… par un autre produit chimique

03:19
Dans les supermarchés, rien n'est laissé au hasard

03:16
Les nouveaux sodas : un peu de stevia, beaucoup de sucres

07:47
Le safran, si cher mais si bon !

03:53
La stevia, la nouvelle mine d'or chinoise

05:41
Naturelle, la stevia… vraiment ?

05:31
L'oeuf est-il bon pour la santé ?

07:20
Cuisiner de bons plats avec des conserves, c'est possible !

47:38
Restaurants : quand la cuisine sous vide devient la norme

07:01
L'Angleterre, l'autre pays du fromage

04:27
Comment la stevia est transformée en sucre blanc

06:30
Les piments, apprenez à les apprivoiser !

07:22
Quand les chefs français se mettent au hamburger

07:07
Allergiques, la galère des repas !

07:35
Ils sont jeunes et rêvent de devenir poissonniers

39:10
Huile d'olive : la face cachée du produit miracle

07:20
Qu'y a-t-il vraiment dans les saucisses ?

06:45
La cuisine éthiopienne, la plus conviviale du monde

07:13
Confitures de légumes : surprenez vos convives !

03:06
Les restaurants chinois font venir les chefs français pour gagner une étoile

04:05
Son étoile Michelin l'oblige à dépenser des fortunes

05:10
Plateau-télé : laissez parler votre imagination !

06:34
Lunch box, bento : manger sain et pas cher au bureau, c'est possible !

05:41
Le ketchup, les secrets d'une sauce mythique

03:36
A Hong Kong, comment le guide Michelin a changé les restaurants

06:33
Le soja est-il vraiment bon pour la santé ?

03:35
La fille Taittinger égérie de la marque familiale de champagne

20:41
Pink Lady, la pomme universelle

04:23
Jeunes vigneronnes en Champagne elles reprennent le flambeau

28:54
LU : petit biscuit, gros bénéfices

06:11
Ce chef français est devenu une star à Montréal

19:54
¿Qué esconden las pizzas industriales?

21:18
Les emballages de nos aliments sont-ils dangereux ?

07:14
Comment ne plus rater les plats compliqués

03:37
Les étudiants de Polytechnique apprennent aussi à déguster le vin !

22:14
C'est quoi la nourriture du futur ?

52:17
La métamorphose du hamburger en France

06:13
Ail, oignons, échalotes : comment les consommer ?

07:01
Apprenez à manger ces aliments avec classe !

23:53
Le triomphe continu d’une famille de bouchers

06:31
Du champ à l'assiette, vous saurez tout sur l'asperge !

03:08
Mon fils, tu reprendras l'affaire familiale !

22:17
Guillaume Bapst, le businessman des épiceries solidaires

53:19
Alimentation industrielle : qu'y a-t-il vraiment dans nos assiettes ?

07:01
Cuisinez à la cocotte : vous ne pourrez plus vous en passer !

03:12
Pour préparer ce concours de chocolatier, tu ne verras plus tes amis !

07:56
A quel steak haché se vouer ?

06:47
Cuisinez du riz et épatez vos amis !

06:28
Le gâteau au yaourt, l'indémodable qu'on adore

06:43
Où mange-t-on le meilleur cassoulet ?

27:57
Yaourt tradition : vieux pot, nouvelle fortune !

06:33
Aliments complets : pourquoi sont-ils meilleurs pour la santé ?

09:54
Je veux décrocher mes deux étoiles au Michelin !

06:59
Comment réussir un goûter d'anniversaire pas cher

06:17
Laissez-vous surprendre par la cuisine belge

12:54
De la viande à prix d'or : les bouchers stars

06:29
Les secrets d'une bonne pizza maison

14:00
Concours : les JO de la cuisine

03:04
Les invendus, la bête noire des supermarchés

20:40
Comment acheter sa viande moins chère ?

06:05
Dans l'artichaut, rien ne se perd !

03:11
La bataille sans merci des supermarchés concurrents

14:05
La Grande Epicerie de Paris : luxe et démesure !

51:34
Ces aliments sains qui nous empoisonnent

06:58
Comment cuisiner avec peu de moyens ?

07:31
Comment réussir de bonnes brochettes ?

06:14
Organiser un pique-nique gastronomique

07:56
Redécouvrez les bonbons de votre enfance

01:19:59
Le business de l'eau en bouteille

07:08
La brioche dans tous ses états

06:38
Vous allez aimer la betterave !

03:07
Branle-bas de combat au supermarché avant l'ouverture

07:04
Redécouvrez les herbes de Provence

07:29
Régalez-vous avec la mozzarella

06:41
Manger des fèves, que de bonnes raisons !

06:24
Les fromages des enfants s'invitent à la table des grands

07:38
A Pékin, les amoureux de la cuisine française

06:46
Au Laos, on adore manger des insectes !

04:08
Ils ouvrent leur boulangerie à plus de 80 ans

01:12:34
Hygiène, arnaque, intoxication : la police des assiettes sur tous les fronts

03:08
Papy rêve d'ouvrir sa boulangerie, mais la famille n'est pas du même avis !

06:44
La plancha, l'essayer, c'est l'adopter !

12:44
Coquilles Saint-Jacques : à la recherche de l'or blanc

27:48
Restaurants de Cassis : qui attirera le plus de touristes ?

04:12
Elan de solidarité envers deux boulangers de 80 ans

07:48
Cet homme est le meilleur maraicher de France

06:54
Le succès fou de la cuisine thaï

07:37
Cuisiner des meringues, un jeu d'enfant !

28:39
Pourquoi les fruits n'ont-ils plus de goût ?

05:47
Gourmande et légère, craquez pour la figue !

05:34
Pêches, nectarines, c'est l'été !

06:45
Cet été, optez pour la limonade !

11:12
Le secret des piments mexicains

52:31
Fraises : un parfum de business

04:10
Il a réalisé son rêve d'ouvrir sa boulangerie à 84 ans

04:21
10 jours après l'ouverture de sa boulangerie, c'est la désillusion

03:19
Salade de concombre façon Tzatziki - Méthode Montignac

05:02
Aubergines confites au Miso - Méthode Montignac

29:08
Kebab : plus fort que le burger ?

06:25
La saucisse de Toulouse est-elle la meilleure saucisse de France ?

05:13
Encornets au Chorizo - Méthode Montignac

17:50
Michel et Augustin à la conquête des Etats Unis

23:26
Jeunes pousses : pourquoi les supermarchés se les arrachent

06:40
Existe-t-il des chips bonnes pour la santé ?

06:51
Scrap cooking : cuisinez des gâteaux oeuvres d'art !

09:10
Qu'y a-t-il vraiment dans nos saucissons ?

07:21
Et si on faisait notre propre huile d'olive ?

24:51
Champagne : que cachent les bulles discount ?

07:11
Le drive in s'impose en France

06:17
Faire aimer des tripes au maroilles aux enfants... défi relevé !

07:41
Comment réussir un bon risotto

29:37
La Mozzarella di Buffala : le trésor caché de la Campanie

06:31
Les meilleures recettes de gaufres

06:36
Le serveur pas sympa, mythe ou réalité ?

07:32
Vous êtes plutôt cuisine à l'huile ou au beurre ?

41:06
Les Rois du Burger

07:28
La cuisine pour trouver l'amour !

07:00
Devenez un expert du barbecue

06:28
Le revival de la nappe

04:46
Apprendre à parler comme un chef

06:45
Les goûters pour enfants

08:56
Pâtes fraiches VS pâtes sèches

06:23
L'oursin, le caviar de la Méditerranée

01:48
Vrai/Faux sur le beurre

06:15
Le championnat de France des Arts de la Table

03:30
Connaissez-vous les restaurants caméléon ?

06:03
Les boulangers artisanaux face aux industriels

12:57
Stéphanie Lequellec, star de la gastronomie française

06:03
Que vaut la cuisine sous vide ?

08:40
Temps de crise : le boom des restos à volonté

06:51
Découvrez la cuisine africaine

06:27
Buffets sur rails, vraiment un bon plan ?

05:13
Son camion à burger a conquis la capitale

26:29
Crêpes, un business en or !

23:21
Bols de céréales : enquête sur les géants du petit déjeuner

20:24
Economies en cuisine : la folie des robots ménagers !

06:10
Je cuisine avec les fleurs

43:20
Ecole Ferrandi: la élite de la gastronomía francesa

04:11
Un restaurateur cuisine des repas de chef pour les soignants

26:01
Coulisses des plats ultra frais : les secrets de fabrication et de conservation

06:34
Nouvelles recettes de popcorn : des idées gonflées

08:05
Les rois des éclairs

21:52
Tapas, apéro : enquête sur le nouveau business des bars

51:14
Les chefs des Outre-mer

20:17
Le camembert français à la conquête du monde

06:33
Les nouvelles pâtes de fruits

24:57
Michel & Augustin : ils ont conquis nos supermarchés !

07:33
La noisette sous toutes ses formes

13:37
Manger moins cher : la guerre au gaspillage

06:46
Je fume moi-même mes aliments

06:08
Les tireuses à bière 2.0

07:50
L’offensive du burger haut de gamme

24:33
Jus de fruits multivitaminés : que buvez-vous vraiment ?

27:32
Derrière les oeufs bio...

50:14
Ananas, le roi des fruits

08:20
3900 litres d'eau pour produire un poulet !

20:02
La livraison à domicile révolutionne le marché de la pizza

24:21
Je mange sain : quand le soja envahit les rayons

24:33
Promos : des dîners à prix cassés

27:34
Les produits locaux au secours des cantines

13:38
Cookies, le biscuit de notre enfance

24:20
Mon pâtissier me vend de l'industriel

23:59
Labels : la folie du « Made in région »

01:37:58
Quelle eau buvons-nous vraiment ?

23:36
Produits du terroir : un retour en force

20:27
Ruée sur les cours de pâtisserie

24:27
Les aventuriers de la cuisine asiatique

40:03
Immersion au coeur des vendanges

28:06
Brasseries : les Auvergnats font la loi !

01:29:19
Detrás de escena de nuestras panaderías

20:54
Buffet libre, la fórmula mágica del fin de semana

45:01
La frite, secrets d'une star mondiale

23:10
Distributeurs automatiques : petites faims et gros profits

44:54
La meilleure pizza de France

43:16
Steak haché, que mangez-vous vraiment ?

29:36
Grignoter sans les kilos, peut-on vraiment craquer ?

13:01
Le donut, la star des beignets

36:01
L'amande, super aliment ou super business ?

24:25
Son rêve, ouvrir un street food asiatique

05:12
Comment convertir vos enfants aux légumes ?

23:45
Le grand gâchis des emballages alimentaires

26:31
Le sauveur des restaurants

03:42
Se régaler avec du céleri

25:54
Les secrets de nos capsules de café

19:54
Valrhona, le chocolat préféré des pâtissiers

50:08
Les pâtes, du blé à l'assiette

05:52
La noix, le délice de l'automne

02:32
Cuisiner le meilleur risotto

51:05
Les mystères de l'oeuf

06:44
Au paradis de la bonne bouffe

07:24
Les pains de nos régions

03:59
Comment faire manger du potiron aux enfants ?

01:24:17
Faut-il avoir peur de manger ?

06:54
Châtaigne, cuisinez le fruit star de l'automne

20:03
Prosecco, le vin pétillant italien qui a conquis le monde

43:59
Le duel américain: les restaurants aux saveurs US s'affrontent!

04:53
Gatronomie, les Japonais plus forts que les Français

29:37
Fruits frais prédécoupés, l'incroyable succès

08:31
Comment la tisane est-elle devenue la boisson cool ?

07:56
Les salades bio, c'est son crédo

04:39
Des recettes de grands-mères... aux additifs alimentaires

22:52
Les secrets des pâtissiers haute couture

14:18
Julia Sedefdjian, une étoile est née

05:18
Un colorant très controversé dans nos céréales

07:12
Les agrumes, nos amis pour l'hiver

05:38
Un laboratoire spécialisé dans les additifs alimentaires…

03:47
Il collectionne toutes les boîtes de céréales !

04:12
Qu'y a-t-il vraiment dans ces carottes râpées ?

06:17
L'homme qui a fait plier McDonald's

09:24
Clémentines, les secrets de notre fruit d'hiver préféré

06:01
Un palace au budget cuisine... illimité

50:39
Le piment, l'épice la plus consommée au monde

07:24
Grenade, le fruit miracle ?

41:47
Rungis, la folie des fêtes de Noël

06:07
Et si on mangeait de l'Aloe Vera ?

15:28
Le meilleur pâtissier du monde

03:20
Le meilleur tiramisu

18:45
Que cachent les bûches de grande surface ?

01:34:55
Noël gourmand, les produits stars du réveillon

13:59
Le roi de la bûche de Noël

07:23
Les agrumes les plus surprenants

01:37:24
Les délices des Marchés de Noël

26:54
Elevage de crevettes, ce que cachent nos repas de fêtes

17:39
Thé, une boisson qui vaut de l'or

35:57
Barilla, des pâtes à la conquête de la France

51:19
Une révolution dans la restauration: la livraison à domicile

26:42
Ils ont tout quitté pour ouvrir un bar

04:05
Pourquoi un petit producteur français a-t-il tant de mal à s'en sortir ?

05:43
Comment faire manger des choux de Bruxelles à vos enfants ?

07:57
La folie des gaufres

20:15
Le meilleur fromager du monde ?

03:08
Dans les "cuisines" d'une pizza discount…

22:10
Comment ces restaurants arrivent-ils à maintenir leurs prix bas ?

03:28
Le pan bagnat revisité

03:08
Jambon bas de gamme pour pizza à bas prix …

33:23
Chefs japonais, chefs français, qui sont les meilleurs ?

06:50
Gluten, faut-il vraiment le bannir de nos assiettes ?

03:22
Du fromage sur les pizzas industrielles, vous êtes sûr ?

06:50
Régalez-vous avec les autres oeufs

34:47
Les rois du poisson depuis 5 générations

15:07
Quand la forêt nous nourrit

03:34
D'où viennent les tomates de nos pizzas ?

52:00
La feta, le fromage grec qui a conquis nos assiettes

04:01
L'histoire de la capsule Nespresso

07:02
Umami, le 5ème goût délicieux

14:11
Le grand retour de la barbaque

50:28
La véritable histoire du maïs

03:10
Les frites, un danger pour notre santé ?

03:20
Le jus de fruit est plus sucré que le soda…

03:03
Le paradis de la nourriture italienne

51:11
La face cachée des raviolis

04:39
Multimilliardaire grâce à la frite

04:55
Dans les coulisses d'une usine de pâtes fraîches

04:08
La truffe, la grande fierté du Périgord

06:07
40 ans de baraque à frites

25:24
Bio, sain et pas cher, c'est possible ?

03:25
Un boucher à succès

41:39
Halles de Narbonne, au royaume des saveurs

03:09
Française ou belge la frite ?

03:09
Un bon jus de fruit aux pesticides

06:41
1001 façons de faire une tarte

04:01
Il a trouvé la truffe parfaite !

51:21
Qu'y a-t-il vraiment dans nos hamburgers ?

04:44
C'est ici que poussent les meilleurs légumes du monde

06:37
Les secrets d'un bon gratin

05:41
Quand Subway s'attaque au géant Mcdo

06:35
Ces légumes tant détestés

05:32
Ils misent tout sur la viande végétale

05:26
Ce qui se cache derrière les étiquettes de nos aliments…

29:23
Weight Watchers : quand vos kilos en trop valent des milliards

26:28
¿Cuál es el impacto de nuestra dieta en nuestro cuerpo?

04:04
La frite, c'est bon quand c'est gras

03:34
Du bisphénol dans nos assiettes

07:19
Le saumon, trop pollué ?

03:04
Ces astuces des industriels pour vendre leurs pâtes

07:12
Réussir une vraie crème dessert

29:03
Les secrets des aliments du quotidien

06:45
Viande industrielle, savez-vous ce que vous mangez ?

03:20
Ses légumes sont uniques au monde !

05:36
Non, les pâtes ne font pas forcément grossir…

06:07
Une fraude au poisson bien rentable

45:56
Le Trident d'or, le Top Chef des armées

05:04
La vérité sur les produits allégés

03:06
Bon appétit 2.0

06:09
C'est ici que naissent les pâtes Panzani

06:01
Peut-on manger du surimi sans danger ?

23:07
Clémentines, les secrets du fruit fétiche de l'hiver

05:03
Ils sont traders en viande industrielle

50:38
Curcuma, aliment miracle ou poudre aux yeux ?

15:23
Petrossian, le tsar du caviar

05:28
Cette bouillabaisse a un goût de vase

03:21
La Grèce, l'autre pays du fromage

10:22
Le piment d'Espelette, la fierté basque

03:53
La meilleure pizza de Marseille

12:30
Il vend du fromage anglais... aux Français !

14:11
Au Japon, on se baigne dans le Beaujolais !

04:45
Deux chefs étoilés dans une cuisine

17:15
Arômes naturels ou artificiels, comment ils ont envahi nos assiettes

04:08
Comment y voir plus clair au rayon pâtes

03:55
Dans les coulisses d'une usine de féta

08:11
Au pays du piment

28:55
Pomme de terre, piment, lait : les secrets des aliments

03:27
Perdió 106 libras comiendo solo Subway

05:55
Dans les coulisses des plats préparés

08:54
Féta ou faux fromage à la Grecque ?

03:32
Les chefs étoilés se battent pour cuisiner ses légumes

03:50
Dans les coulisses d'un géant de l'oeuf

40:17
Domaine de Murtoli, le trésor gardé de la Corse

15:00
Guillaume Gomez, le chef des cuisines de l’Élysée

04:15
Le piment, un vrai allié santé

05:47
Des desserts aux... légumes !

27:05
Pierre Hermé, l'inventeur de la haute pâtisserie

06:57
Le café et les Français

07:14
Je ne mange plus, je grignote en permanence

07:35
A los 12 ya es chef

05:51
Le sel se cache partout

28:51
Plongée dans les mythiques Halles de Lille

05:32
Street food, la solution des pressés

06:25
La vérité derrière les pizzas surgelées

06:34
Aujourd'hui, je cuisine des tripes

07:45
Le Top Chef de la crêpe

49:49
La guerre des fromages qui puent

06:14
Les bienfaits des produits complets

07:10
Manger moins vite, ça s'apprend

13:44
Christelle Brua, meilleure pâtissière au monde

06:38
Le burger a remplacé le boeuf bourguignon

01:33:39
Thierry Marx : l'école de cuisine de la seconde chance

06:18
Dans le poulpe, il n'y a que du bon !

05:45
Comment rattraper les plats ratés

03:48
Le roi de la frite au stade de Lens

07:28
Il est vraiment trop mauvais en cuisine !

03:14
Un petit bout de Grèce à Paris

24:40
Les "superfruits" : miracle ou marketing ?

09:10
La gastronomie en barquette

09:58
Un menu étoilé à 18 euros

03:13
La vérité sur les oeufs plein air

05:31
Le bon plan pour payer sa viande moins cher

05:46
La folie de la plancha

05:01
Ces robots qui cuisinent à notre place

27:31
Voyage au pays de l'ananas

03:18
Un des derniers ateliers de pâtes artisanales

10:55
A la recherche du piment d'exception…

26:56
Du producteur au consommateur : la bonne affaire ?

07:33
L'huile d'olive, un business très juteux

03:51
Ce chef étoilé se fournit dans les quartiers nord de Marseille

13:44
Quand la crêpe fait sa révolution

03:18
Je suis cuisinier sur un… sous-marin !

04:15
50% de la nourriture est jetée à la poubelle

27:09
Sucre, ce que dit vraiment la science

03:39
Le secret de sa feta artisanale

04:38
Pâtes : grandes marques VS marques distributeurs

06:23
Qui aura le meilleur flan pâtissier ?

07:19
Elle ne cuisine qu'avec des arômes artificiels

04:19
Une petite leçon de cuisine pimentée

03:01
Subway, la concurrence diététique de Mcdo ?

03:36
Du porc caché dans des cheeseburgers... au boeuf

15:20
Le mondial de la fondue

05:38
La myrtille, pour la gourmandise et la santé !

14:34
La folie des tacos

15:49
Un chef pour booster un resto en panne

03:34
Pâtes industrielles : attention danger ?

51:38
A la découverte des vins naturels

05:16
Il prépare un cornet de 6 tonnes de frites

09:55
Ces oeufs que les industriels utilisent…

06:11
La framboise, un fruit fragile mais si bon !

03:05
Boucherie VS supermarché

05:37
La fraise française fait sa révolution

01:00:32
Restaurant : dans l'enfer des cuisines

06:40
La cuisson en sachet, une méthode idéale ?

04:05
Produits à base de piment, méfiance…

03:09
Le Mirazur, uno de los mejores restaurantes del mundo

05:58
Comment bien choisir son melon ?

27:56
El negocio halal

25:16
Couteau en céramique : de l'artisanat japonais à la cuisine moderne

05:17
Les raviolis ont envahi nos assiettes

06:44
Quand la cuisine envahit même les séries

08:18
Comment se régaler en réinventant le croque-monsieur ?

05:34
Patatas fritas prácticamente sin aceite

07:00
La guerre des rillettes

23:06
Rosé, les secrets du vin de l'été

04:24
Dans les cuisines des buffets à volonté

06:32
Des plateaux repas diététiques

07:07
La revanche des fruits et légumes moches

05:18
Personnalisez vos glaçons

23:04
Les secrets de la pomme, les oeufs d’escargots et les céréales

07:08
Salade niçoise VS salade gasconne

07:04
Le pâtissier des stars

07:12
La guerre des boudins

06:11
La vinaigrette dans tous ses états

03:14
Las vacaciones de un gran chef en Saint Barth

06:29
La cuisine brésilienne

24:15
L’autruche, le cassoulet et tout savoir sur l’eau

05:46
Le barbecue light, c'est possible !

42:29
Le Sirha, le salon de la cuisine du futur

14:23
Hugo Desnoyer, la star des bouchers

52:00
La route des vins à New York

25:05
Le roi de la boulangerie au Chili

26:55
Glaces de luxe : la guerre est déclarée

10:09
Yves-Marie Le Bourdonnec, le boucher des viandes d'exception

03:22
Régime citron, info ou intox ?

23:37
Fruits et légumes, le grand retour des halles

51:06
La route des vins en Uruguay

21:40
Tilapia, le poisson miracle

07:39
Qu'y a-t-il dans ces crêpes industrielles à 4€ ?

05:53
Chez Jules, le meilleur restaurant du Leman

51:51
La route des vins en Australie Méridionale

06:55
Des conserves avec des légumes moches

07:11
Que se passe-t-il dans notre cerveau quand nous mangeons ?

18:45
Quand les hypermarchés parient sur le terroir

28:37
Le thé vert, sur les traces de la feuille miraculeuse

13:39
Laurent Tourondel, le chef businessman

48:57
Sur la route des vins au Mexique

05:54
Cultiva papas para McDonald's.

03:29
La gran moda de la pasta fresca

04:20
Les pasteis de nata, un délice venu du Portugal

51:59
Sur la route des vins en Australie, Nouvelle-Galles du Sud

13:01
Moelleux au chocolat, l'incontournable dessert

04:07
Les secrets d'une bonne paella

03:02
Le steak du futur...

51:19
Sur la route des vins au Maroc

06:49
Faites de vos plats des oeuvres d'art

07:34
Les fritures light

04:33
Des tomates séchées express

02:52
D'où vient vraiment l'huile d'olive italienne ?

07:02
Conserves VS Surgelés : le match

06:54
Le granité, la fraîcheur de l'été

06:12
La grande mode des biscuits light

05:48
Marché vs Supermarché

06:10
Pâtisseries de chef express

06:35
A la découverte de la charcuterie bordelaise

28:08
Restos à un euro : comment cassent-ils les prix ?

03:06
Ici, les melons sont à 150€ pièce !

03:36
Nos idées reçues sur les épinards

13:06
Le croquant de poire au caramel

06:55
La cuisine confite, un régal

07:00
Comment bien choisir son restaurant de fruits de mer ?

13:08
Le chapon farci

39:54
La Coupole, la renaissance d'une brasserie mythique

13:49
Riccardo Giraudi, le prince de la viande de luxe

13:05
Le poulet à l’ail

03:30
Ce chef japonais a 3 étoiles au Michelin

05:06
Un dîner dans le noir

13:33
Le crabe de tante Marcelle

40:49
Young chef, qui sera le meilleur jeune chef du monde ?

35:58
Déstockeurs alimentaires, comment cassent-ils les prix ?

13:30
Les langoustines aux fèves

03:26
Le roi de la saucisse

39:59
Les incroyables créations du salon du chocolat

13:30
La canette de barbarie

25:31
Resto à domicile, la grande bataille de la livraison

05:00
Le rosé, pourquoi un tel succès ?

13:39
Le lapin farci aux herbes

04:41
Pâtisserie industrielle : 8000 éclairs de l'heure !

13:07
Les beignets d'escargots

29:02
Les tacos, les nouveaux rois du fast food

08:16
Le régime 5.2, la fausse bonne idée ?

13:07
Le pot au feu de poissons

07:11
Cuisinez gourmet avec un micro-onde

06:16
Le bacon, le roi du rayon charcuterie

13:07
La crème anglaise

43:41
La Felicita, au coeur du plus grand restaurant d'Europe

03:26
Le grignotage enfin expliqué

03:15
Le soja serait toxique pour nous

13:38
La sole farcie

07:55
Le meilleur pot au feu de France

06:59
La quenelle fait son grand retour

13:07
Cuisinez le pigeon

29:32
Alimentation, et si c'était nous qui fixions les prix ?

06:39
Huile d'olive, attention à la fraude

06:48
Le concombre, l'allié minceur par excellence

13:38
La lotte aux poireaux

04:59
Supérette ou hypermarché, qui est le moins cher ?

04:06
Un bon rosé, c'est une bonne étiquette

13:10
La soupe de melon au sauternes

51:39
Cornichon, les secrets du condiment préféré des Français

08:13
Un futur meilleur apprenti de France ?

04:19
Est-ce si mauvais de manger trop de charcuterie ?

13:15
La joue de boeuf aux carottes

04:32
Le gingembre, l'allié santé de notre cuisine

06:51
Les douceurs bordelaises

13:28
La pintade fermière

28:21
Le salon du chocolat, l'évènement le plus gourmand de l'année

07:07
Il est le plus jeune chef étoilé de France

06:52
Soupe en brique ou soupe maison ?

07:41
Sa sculpture en sucre est une oeuvre d'art

04:26
Elle monte son restaurant dans sa salle à manger

05:05
Faire son pain surprise, rien de plus simple !

32:20
Supermarchés de producteurs, les nouveaux réseaux

05:14
Des produits frais pour cette cantine

03:36
Quand les artisans succombent à l'industriel

13:09
La soupe aux navets

08:56
Les épinards sont-ils si bons pour notre santé ?

05:45
Il pète un plomb à cause de critiques sur TripAdvisor

05:40
Evian, l'eau minérale qui rapporte

51:56
Conserve, et s'il y avait du bon ?

05:14
Comment se régaler avec les courgettes

05:04
Fleury Michon bichonne ses employés

13:07
Le chou farci aux crustacés

04:28
Un buffet à volonté, le grand bluff

04:00
Il paye en cash pour échapper au fisc

07:10
Vous ne raterez plus jamais vos macarons

27:59
Miami, capitale de la gastronomie

03:21
Remettre le végétal au coeur de l'assiette

07:16
Des crumbles à l'infini !

13:38
Le cabillaud aux moules et aux huîtres

04:03
Impossible de ne pas squatter ce bar

03:45
Le jury du Festival de Cannes va se régaler

05:51
Les fermes de libre cueillette ont le vent en poupe !

52:41
Au coeur de la salade

05:37
Des produits locaux pour les cantines, ça ne s'improvise pas !

13:02
Le pigeon aux petits pois

04:23
Ils vont apprendre à cuisiner avec des baguettes !

03:26
C'est le père de qui ça encore 😂😂

03:02
Ils viennent ici apprendre la gastronomie française

14:46
Défi en cuisine

04:13
Le rosé espagnol, une affaire très rentable

03:30
C'est le plus grand producteur de citrons au monde

13:38
Cuisiner du foie gras

04:05
C'est ici que les raviolis sont fabriqués

04:43
Ce chef français vient chercher ici les meilleurs poissons du Japon

04:24
Ces conseillers municipaux jouent aux goûteurs pour leurs cantines

41:00
Eataly, Noël à l'italienne

05:21
De la pâtisserie industrielle avec le look du fait maison

07:02
Les "coupe faim" naturel, le régime miracle ?

13:31
Cuisiner une cotriade de poissons

03:14
Quand le soja devient viande

05:20
Il faut arriver tôt pour déguster ses buches de Noël

06:17
Les secrets du mille feuilles

01:36:02
Pâtisseries, restaurants, artisans : nos commerçants à la conquête du monde !

03:19
5 repas par jour pour ces ados obèses

07:51
La plus grande omelette du monde

13:38
Cuisinez une selle d'agneau farcie aux herbes

06:23
Foie gras français fabriqué en Bulgarie

05:18
Un steak végétal au pays du burger

07:36
Les bûches de Noël light

47:01
Picard : les secrets des rois du surgelé

03:45
Restaurant d'altitude, faut pas se louper !

05:45
Réveillon low-cost

07:44
Les néophobies, ou la peur de manger de nouveaux aliments

07:20
La cuisine se plie en 4

05:40
Ce qu'on mange en 1ère classe chez Air France

19:39
Soupe, le bon filon du rayon frais

03:18
Gault et Millau, un guide d'amateurs passionnés

07:29
Inspection d'hygiène dans un kebab marseillais

03:56
Le glaçage, le petit plus qui fait la différence

06:48
Le concombre, notre légume préféré

06:52
Des gnocchis à toutes les sauces

21:08
Oranges pressées, le top pour la santé

03:22
C'est le roi de la mer bretonne

06:50
Un voyage culinaire en Turquie

03:10
Des produits avariés dans les snacks marseillais

04:20
Sublimez vos desserts avec les tuiles

06:35
Les eaux minérales peuvent être dangereuses pour la santé

04:07
La fabrication de la viande du futur...

06:24
Quand le luxe s'empare du créneau de la livraison de repas

07:31
Les boulettes en vedette

23:13
Chef Club, la recette du succès

05:05
Picard : Le roi du surgelé moins cher que le frais

03:15
On s'est invité à déjeuner avec une critique du Gault et Millau

07:03
Laissez le chou-fleur vous surprendre

06:24
Un repas 100 % pistache

04:17
Les secrets du homard avec Patrick Jeffroy

59:28
Que mange-t-on au Palais de Monaco ?

03:11
Les petits fours surgelés sont faits à la main

06:30
Tout est bon dans la semoule !

06:13
Les secrets d'une bonne socca

05:14
La courgette est toujours facile à préparer

07:13
Tout est dans la farce

06:43
Dans les coulisses des restaurants de lieux touristiques

52:15
Roquefort, secrets de fabrication de la star des fromages

03:15
Il est la bête noire des restaurateurs

05:52
Dans cette école, ce sont les enfants qui cuisinent

05:34
Cette critique culinaire teste un resto routier

05:17
Ce pâtissier est un spécialiste du gâteau d'anniversaire

04:43
Compétition de fondues en Suisse

05:27
Les restaurants gratuits, le bon filon

27:42
Alimentation, le prix du gâchis

06:32
Les douceurs culinaires de Toulouse

03:05
Le jour où Mac Do a arrêté les pailles

07:59
Il vous nourrit dans des conditions extrêmes

05:03
Les soupes en brique, une arnaque dévoilée

06:24
Méfiez vous du parmesan made in USA

07:09
La cuisine renversée et ses secrets

06:52
Le sirop d'érable, le sucre santé

27:26
Robots cuiseurs, tous à l'assaut de Thermomix !

03:53
Ils imposent la France à Miami

03:22
Les arômes artificiels, l'ingrédient caché des restaurants

06:30
Les religieuses se transforment en Willy Wonka

26:41
Hot dog, barbecue et restaurant étoilé : bienvenue à New York !

04:38
Plats surgelés, comment les restaurateurs nous arnaquent

04:21
La fabrication du fromage, un vrai travail d'alchimiste

04:19
Les jus fraîchement pressés des supermarchés sont-ils si sains que ça ?

07:22
Le conclave des pâtissiers, alias le club des sucrés

13:51
La brioche, la reine de nos petits déjeuners

03:39
Quand les poissons mangent du plastique

03:03
Son épicerie fine est divine !

04:58
Il veut vendre ses olives niçoises aux anglais

04:12
Les boulangeries en Chine ne connaissent pas la crise

04:04
L'innovation, la dernière tendance du snacking

03:10
Cette française séduit Miami avec ses confitures

03:29
La nouvelle position des enseignes discount pour vendre leurs produits

07:43
La cuisine mauricienne, testée et approuvée par les touristes

24:18
Resto, fast food, vers la fin du plastique jetable ?

08:27
Quand le roquefort s'attaque aux chinois

03:56
La Cornue, la rolls des cuisinières

03:11
Emmanuel Bombardier, le grand gagnant du concours de sushis

03:16
La dernière innovation de Zummo pour s'imposer dans le business du jus d'orange

07:10
Une boucherie en ligne pour satisfaire les carnivores

03:09
La brigade du parmesan passe à l'action

29:19
Produits bios de supermarchés, peut-on leur faire confiance ?

04:41
Son concept de soupe fraîche anti-gaspillage fait l'unanimité

06:23
Aude participe au concours du meilleur burger de France

03:08
Une table de 90 couverts plus longue que la rue

06:25
Pourquoi nos escargots ne sont plus élevés en France ?

04:25
Gagner du temps et de l'argent avec des plats industriels pour leurs resto

03:53
Il est devenu indétrônable sur le presse agrume professionnel

01:26:58
Le terroir made in France existe-t-il encore ?

03:21
Elle fait de la glace au roquefort 😅

03:39
Pourquoi un plat à la truffe siphonne votre porte feuille

07:08
Les chinois s'arnaquent eux-mêmes sur le vin français

06:37
Des Belges ouvrent une sandwicherie à Medellín

07:29
Elle mange équilibré pour quelques euros par jour

03:32
Quand l'abbaye tourne au chocolat

28:06
Bières artisanales, pourquoi les Français en raffolent

03:53
Un lait d'exception pour le roquefort Carles

03:21
La brasserie Kronenbourg, la plus grande de France

03:07
Ici sont fabriquées les céréales de votre petit déjeuner

04:53
L'ormeau , un coquillage hors du commun

04:05
Supercoop, un supermarché caché pour faire de bonnes affaires

03:23
Cette cuisinière avertie affectionne les conserves

40:11
Burgers, pizzas, sushis : qui sont les rois du snacking ?

07:02
Un restaurant bien perché

06:45
La mangue par bateau ou la mangue par avion ?

04:03
L'arnaque des faux fromages basques

03:06
La fameuse recette du moelleux au chocolat

04:19
Hervé ne fait pas dans la dentelle avec ses courges

04:16
Vous prendrez bien un peu de ragondin pour le diner ?

41:37
Pâques : la bataille du chocolat

09:56
La salade est elle vraiment bonne pour la santé ?

03:13
Ils achètent de la piquette à 15 000€ la bouteille 😶

03:35
Une nutritionniste fait tester des raviolis en boite à ses enfants

04:28
Le français aime la moule

05:00
Fruits et vitamines, pensez-y !

04:47
La ganache, les secrets des maîtres chocolatiers

15:28
Panique en cuisine ! Une école pour les restaurateurs en galère

08:29
Il a inventé les pastas box

06:54
Tout savoir sur les oeufs que vous consommez

04:18
Gust, le bar à salades qui casse les prix

05:31
Pas facile la vie d'un Curly en production

06:06
Les eaux néfastes pour notre santé

03:08
Les astuces de ce chef pâtissier pour trouver l'inspiration

51:41
Industriel, fermier, fait maison : les secrets du yaourt

03:12
Hugues et Jonathan passent en mode conquête asiatique

05:25
Voici les plus gros œufs du monde

03:08
L' astuce minceur de la taille de l'assiette

03:11
Un lait qui fait le bonheur de ses producteurs

03:39
Rien n'arrêtera Hugues pour implanter son bourgogne à Hong Kong

49:54
Restaurants : du surgelé dans nos assiettes ?

05:11
Eric doit sa renommée à son cassoulet

05:00
Jean François au temple de la nouille

07:38
La Normandie, le royaume de la crevette

03:04
Ici, la bataille est rude dans l'univers du fromage

03:06
Les étudiants, fan numéro 1 des pasta box

04:36
Sandra plaque tout pour ouvrir une pâtisserie de luxe à Hong Kong

29:25
L'Après M : l'ancien McDo devenu fast food solidaire

07:37
La poubelle, le destin de millions de yaourts qui peut être évité

05:44
Le gras, uniquement source d’inattentions

05:45
Les secrets de la fabrication du champagne

06:06
Le business vert, le meilleur livré à domicile

03:55
Faites du caviar avec des escargots

06:53
Le gaspillage des denrées alimentaires des supermarchés

06:52
A la recherche des meilleurs fromages de France

35:58
Barbecue, un marché juteux à plusieurs millions d'euros

03:42
Laure part en quête de fromages made in USA

09:05
La salade industrielle, de l'autre côté du rideau

06:34
El yogur, una tradición ancestral búlgara

08:49
En Colombia, la maracuyá es una pepita de oro

06:50
Cómo cosechar con éxito tus setas

04:46
Probamos un auténtico almuerzo libanés

27:25
Tomates cerises, petit plaisir, gros business

04:29
Orgánico, ¿un precio muy justificado?

03:08
Nueva York, la ciudad donde reina el brunch

05:37
Vino en China, ¿un pase para hacerse millonario?

05:47
En 20 años, el volumen de queso de granja se ha multiplicado por 1000

06:01
Panqueques actualizados

01:30:01
Les aventuriers du terroir : ils se battent contre la malbouffe

07:59
Le Pain Quotidien hace trigo con los brunches

03:01
El tomate cherry, ¡el rey de la barbacoa!

04:05
Foie gras semicocido al alcance de todos

04:12
El buen negocio de las barras de ensaladas

07:13
Los secretos sesgados de los jugos de frutas multivitamínicos

03:14
Hacer tus propios yogures es más barato y tu cuerpo te lo agradecerá

51:16
Vous saurez tout sur le kiwi

03:50
A Hong Kong, elle galère pour vendre ses petits choux

03:03
Demasiada demanda en Francia de agricultura ecológica

05:13
Paté de Hénaff, un asunto de familia

08:28
Tout savoir sur l'eau plate et l'eau pétillante

03:27
C'est le seul restaurant chinois étoilé de France

03:02
Le moelleux industriel anglais face au moelleux de pâtisserie

27:04
Tous contre Thermomix, la guerre des robots de cuisine

05:56
Des supermarchés font pousser leurs aromates 👏

04:56
La bisque de homard véritable

03:21
Él bombea todo en O'Tacos por su señal

13:18
Les orfèvres du chocolat

03:12
Orgánico, una demanda cada vez mayor que los supermercados ya no pueden satisfacer

04:02
Sébastien Bouillet y su fábrica de chocolate de cuento de hadas

01:24:43
Hypermarchés des plages, au coeur du grand rush de l’été

03:34
Voss, 9 euros por beber agua del grifo...

03:31
Ella busca producir la supermodelo del tomate cherry

03:37
Francia VS Marruecos, ¡un concurso de belleza despiadado!

03:56
Cultivo de tomates cherry sin pesticidas

06:36
En busca de los falsificadores de vino

03:46
Andalucía se ha convertido en el granero ecológico de Europa

52:30
Les restos routiers : cuisine familiale, qualité et bon accueil

04:43
Aquí Mickey pondrá a prueba tu estómago

03:53
Comedores de oficina, un aliado para adelgazar por menos de cuatro euros

05:32
Los supermercados también se están pasando a los cupones digitales

04:21
Biografía, ¿una gran estafa?

06:34
Este francés ha creado el pequeño cebo móvil perfecto

06:42
Cómo limitan los supermercados las roturas con productos no vendidos

01:47:57
Moins industriels, plus authentiques : pourquoi les produits locaux séduisent-ils les Français ?

03:47
Una nueva etiqueta supuestamente para proteger la salud de los consumidores

03:03
Mi fuente de agua me aporta millones de euros

03:13
El Bio francés, ¿un gran engaño?

06:23
El tomate cherry, una mina de oro para esta jardinera

09:55
La cerveza fluye a través de la carpa del león del Oktoberfest

05:54
Los grandes minoristas reducen los residuos, en detrimento de los fabricantes

25:35
Comment Weber est-il devenu le maître du barbecue ?

04:25
Claude Troisgros, un hombre que empieza de cero

06:52
Vincent Vergne nos presenta los mejores quesos de Francia

04:47
Día D para Jordania con el concurso del mejor sushi de Francia

04:01
Cola de una hora para el brunch del domingo.

06:15
Luchan contra el desperdicio por fechas de caducidad

03:48
En Bulgaria, los cultivos de yogur son un tesoro nacional

52:04
Le citron est-il l'aliment parfait ?

06:19
Estos bombones son obras de arte.

08:57
Una batalla arancelaria por dominar la región

03:16
Quand les cantines se livrent bataille pour une place chez les costumes-cravates

03:31
Cómo se mantiene la bio bajo control

09:13
Capón relleno, una receta para seguir al pie de la letra

07:52
La famosa receta de lomo de cordero relleno de hierbas

51:37
La mangue, les secrets du fruit exotique le plus consommé au monde

06:41
La receta de natillas y huevos de nieve en un clic

09:36
El descarado negocio de la barra de ensaladas

05:10
Voló una colina para hacer su bodega de queso

06:32
Carrillera de ternera con zanahorias al alcance de la mano

09:28
La cara oculta de los yogures de campo en los supermercados

04:10
Leclerc vs Super U: La batalla de la conducción

40:05
Au coeur d'un restaurant de Yannick Alléno, le chef aux 13 étoiles

03:12
Adrien se gana bien la vida con sus bebés de 800 kilos

03:13
Comment réussir une Bruschetta ?

03:29
Huître gratinée champagne et morilles

03:07
Las marcas de supermercados crean sus marcas propias

03:19
Queso de granja en auge entre nuestros amigos canadienses

04:04
Para satisfacer a los clientes, los supermercados tiran los productos que no caducan

06:32
Rechazar lo más feo no es bueno para el planeta

04:03
Nada escapa al ojo de la aprobación de un mayorista

13:23
Qui est Hélène Darroze, une des meilleurs chefs du monde

03:28
Vienen a aprender a hacer queso REAL

03:15
El drive, la revolución del supermercado

03:25
Ici, pas question de mettre en boite des sardines congelées

04:25
Este reconocido queso se encuentra en una feroz lucha contra los quesos industriales

03:01
Hugues apunta a fortunas chinas para vender sus vinos

07:05
Cocino mi salmón en el lavavajillas.

23:23
Comment sont fabriquées les pâtes fraiches de supermarché ?

04:11
Este exjugador de rugby se convierte en el salvador de los restauradores en apuros

04:00
L'organisation militaire des cuisines d'un bateau de croisière

04:42
D8, un auténtico superhéroe que siempre velará por tus pausas para el café

07:49
El truco de magia de las cocinas escolares para abaratar costes

06:31
En Groenlandia nos metemos en la barriga todo lo que encontramos

05:29
Nadège abre un salón de té en Toronto en un abrir y cerrar de ojos

27:17
Café Nespresso, d'où viennent vraiment les célèbres capsules ?

04:18
Este chef 3 estrellas recibe un cliente que puede cambiar su carrera

03:17
Mango, la fruta perfecta para consumir todo el año

07:59
Estas máquinas esenciales donde el oro negro fluye libremente

04:20
Realiza impresionantes obras de arte en chocolate.

06:55
Cuando nuestros hijos comen desperdicios de mercado en la cantina

04:21
En el Festival de Cine de Cannes, no solo hace calor en la alfombra roja

13:41
Mes bouteilles valent plus qu'une voiture

03:32
¡Esta área de catering corporativo es el rey de las pretensiones!

03:57
Aquí, el toque blanco requiere alma de artista

05:04
El agua de los cubos de hielo tiene 200.000 años

04:46
Esta formidable técnica para saciar a 4.200 ogros

05:08
Yogures industriales, productos más saludables

03:14
Inspection d'hygiène qui finit en cartouche par cet ancien rugbyman

51:32
Oporto: un vino milenario nacido en el valle del Alto Duero | Documental

22:55
La tomme de Savoie, le fromage aux mille recettes

03:01
El polvo en los ojos enviado a los consumidores por los distribuidores de café

03:07
La conserve se met au vert avec la conserve en carton

05:58
"Top Chef" está a tu alcance por unos pocos euros

04:47
Ronde et juteuse, je ne demande qu'à être croquée

03:37
Cuando Danone arruina a los criadores

03:12
En este restaurante de comida rápida las ensaladas son las reinas

22:08
Le Sainte Maure de Touraine, le fromage de chèvre de caractère

03:52
Es la comida más importante del día.

03:10
Uno de los raperos de 113 está reciclando en los tacos

03:00
En Niza, los vestidos de chocolate son populares.

51:54
El prestigioso viñedo de Rioja

02:46
Hizo una fortuna exportando frutas de Ghana

05:05
La cultura razonada de nuestra querida ensalada

04:18
El enlatado y su sorprendente historia

26:09
Le cantal, les secrets du fromage préféré des Auvergnats

52:08
Castillos de Burdeos: Château Yquem y La Torre Blanca

08:05
Moissac motivo, el más dulce del mundo

03:08
Trabajar con Ubereat puede ser costoso para los restaurantes

03:20
El método Yvan, un gran impulsor de facturación

05:43
En este gran restaurante, ¡caminamos sobre cáscaras de huevo!

03:27
El mercado francés, un ogro de frutas exóticas

09:47
¿Un restaurante de hamburguesas en un parque acuático, apuesta y espina en el costado?

50:00
La châtaigne, ce délicieux petit fruit de l'automne

22:32
Le reblochon, les secrets du fameux fromage à tartiflette

03:37
Es el rey de los crustáceos en las Halles de Lyon

05:21
La vaca, una empleada productiva que trabaja gratis

05:54
El secreto de los precios bajos de Lidl

05:29
¡Sus morcillas trufadas venden sueños!

04:41
¿Por qué es tan caro lo orgánico?

26:29
Les secrets du camembert

03:59
A Bastia, elle vend des jus frais artisanaux et ça cartonne

05:42
Les bonbons anciens sont toujours un vrai succès

03:20
Le service parfait du fastfood social de Marseille

03:24
Il faut être patient pour avoir Salt Bae à sa table

03:38
Il va pêcher pour Anne Sophie Pic

03:01
L'homme qui se nourrit de la nature

25:39
Le roquefort, le roi des fromages

03:01
Le pain de Camille met une claque au jury

03:50
Les oranges espagnoles ont le droit à un ravalement de façade avant d'être vendues

03:45
Dans ce restaurant, le black est roi !

03:50
A Vittel, l'eau est un véritable trésor économique

06:18
Il a créé la Pink Lady et ça ne lui a rien rapporté

07:45
Marché VS grande surface, qui l'emporte ?

01:28:00
Supermarchés : les coulisses de la grande distribution

03:45
Lionel se risque dans une recette de burger gastronomique

06:12
Leurs roses vont passer à la casserole

03:40
La pinchonomie, cette étrange cuisine du Pays basque

06:44
Une machine noire pour être le roi de la chips !

05:47
Le mélange herbes et sucres, la dernière tendance culinaire

04:03
Viandards contre végétariens

26:03
Les secrets de la frite : pourquoi tout le monde les adore

07:21
Comment garder la ligne en se faisant plaisir

05:39
La filière du foie gras Français en difficulté

08:31
Les fromages basques en lutte constante contre les industriels

07:05
Chez les fruits et légumes, les plus moches sont les meilleurs

08:01
La molécule de plaisir de la pomme de terre

07:11
Jennifer veut maigrir avec un petit déjeuner raclette

24:59
Le Beaufort, le roi du fromage !

06:25
Poissons, viandes, comment les conserver sans frigo?

03:15
Des gâteaux originaux et faits maison pour les fêtes

06:33
François, 59 ans, fait des prairies un repas de grand chef

06:05
Les secrets de Mamie sont-ils bons pour la santé ?

26:39
Le Saint-Marcellin, le fromage qui vous va bien !

06:58
La moutarde française revient de loin !

09:43
Les secrets de l'orange industrielle espagnole

01:14:52
KFC, enquête dans les entrailles du géant américain

04:41
Les secrets de la fabrication du lait Gloria

10:35
Reenvasado de carne, ¿cómo funciona?

06:55
Le design culinaire, de quoi rendre fous les plus observateurs

08:39
Le Louis XV de Monaco, un lieu idéal pour faire son stage

03:16
22 m² de tarte aux fraises, le record du monde !

25:32
Le Rocamadour, un fromage digne de sa réputation

01:26:36
Supermarchés : les coulisses de la révolution

09:14
Les cuisines de cette pizzeria sont plus sales que les égouts

09:58
Un trafic de nourriture chinoise démantelé

51:17
Sous le soleil Corse : L'Orange et ses racines

40:18
Le jambon, enquête sur la phase inquiétante de sa fabrication

24:04
Pâtes : les secrets du féculent préféré des Français

30:15
Pain artisanal ou industriel, la guerre des boulangers est déclarée

28:10
Allergies, intolérances, comment les supporter ?

40:23
Le salon de la pâtisserie, le paradis des gourmands

52:01
L'histoire de la mozzarella, le fromage le plus consommé au monde

44:07
Les surgelés, amis ou ennemis ?

51:16
Arbre à clous

28:14
La science de vos gourmandises préférées

25:11
Le Picodon, plus coulant que jamais !

48:06
Chocolat y en aura-t-il pour, tout le monde ?

40:19
Tops chefs de la cantoche

23:01
Les arts de la table espagnole

52:29
La grande distribution, une guerre des prix sans pitié !

01:52:16
Le bonheur est dans l'assiette

13:31
Quand la meringue devient tendance

24:03
Restaurant en famille : enquête sur les rois du brunch

27:13
Le comté, ce fromage qui peut nous coucher !

24:35
Fast-food light : le nouveau boom des bars à salades

25:25
Les secrets de la choucroute

06:45
Comment bien choisir ses fruits de mer ?

25:28
La Fourme d’Ambert, quand le vieux a du bon !

07:15
Des huiles pour le goût et la santé

16:44
Les pizzas Big Mama, pourquoi elles sont si bonnes

07:08
Tartes aux fraises, framboisiers, peut-on craquer sans devenir gros ?

39:02
Marché d’Arles : Du soleil en hiver

23:37
Subway : la multinationale du sandwich diététique

23:15
Tout savoir sur le sucre

59:28
Les cuisiniers du Palais de Monaco

51:41
El plátano, la fruta más consumida en el mundo

27:00
Ces Français qui nourrissent Los Angeles

23:35
Les secrets des yaourts

42:10
Manger du bœuf, comment acheter moins cher ?

13:01
Yamashita : le magicien de la terre

42:39
La face cachée des biscuits

52:27
Arnaque à l’italienne, enquête sur un braquage gastronomique

51:45
La bataille du miel

25:26
Un restaurant unique en France

42:01
Enquête sur les produits light

24:34
La saison des vendanges

32:06
Recettes du bout du monde

20:37
Méfiez-vous de la provenance de votre foie gras

25:16
Tout savoir sur le beaufort

24:29
Bons petits plats, la guerre des cocottes

40:19
Les dessous de la cantine

52:39
Les Vins du Nouveau Monde | Nouvelle-Zélande

51:23
Gastronomie : La guerre des étoiles

51:50
Les Grands Vins Français | Vallée Sud du Rhône

01:30:35
Le nouveau boom des produits du terroir

51:11
Les Grands Vins Français | Bordeaux : Château Lafitte et Château Haut Brion

52:35
Les Vins du Nouveau Monde | Afrique du Sud

42:21
La Coupe de France des meilleurs boulangers

53:14
Les Vins du Nouveau Monde | Australie

51:12
Les Grands Vins Français | Bordeaux : Château Cheval Blanc et Château Ausone

41:42
La cuisine du futur

53:52
Les Vins du Nouveau Monde | USA : Californie, Vallée de Santa Barbara et Sonome

26:54
El Kebab atemporal: los secretos del éxito

27:14
Livraison, le boom des repas à domicile

51:14
Les Grands Vins Français | Vallée du Rhône Nord

39:37
Ouverture d'un palace à Dubaï

54:07
La pibale : un plat à 4000 euros le kilo

24:15
La fabrication du jambon basque

52:01
Les Vins du Nouveau Monde | Argentine

08:19
Leche: ¿buena o mala para la salud?

51:01
Vins du Nouveau Monde | Californie, Napa Valley

22:21
Les saveurs du bout du monde

14:57
Les nouveaux supermarchés

11:44
Arnaud Lahrer descubre el chocolate rosa

52:06
Locura del chocolate | Documental en español

41:03
Le concours du meilleur Burger

51:45
Les Grands Vins Français | Bourgogne : Côte de Nuits

25:32
Le boom du Bio

52:40
Les Vins du Nouveau Monde | Chili

17:15
El caviar, este producto de lujo, no siempre es lo que pensamos

51:56
Les Grands Vins Français | Bordeaux : Château Margaux et Mouton Rothschild

07:27
Nueva tendencia: cocina monocromática

52:01
Les Grands Vins Français | Bourgogne : Côte de Beaune

11:44
Jérôme Rigaud recibe a sus homólogos en la cena de los chefs en el Kremlin

17:36
Le Pavillon Ledoyen, un restaurant de plus de 200 ans !

14:57
Córcega, la tierra de las naranjas

53:01
Les plus grands vins d'Italie | La Toscane

11:01
El secreto del buen caviar

52:12
Corse VS Pays Basque : un match explosif

12:59
Baristas, champions de café

14:30
Enquête : la grande arnaque du fait maison

13:56
Le succès de la soupe

14:28
La Pizza, la reine de la crise

11:07
Ces céréales qui nuisent à la santé de nos animaux

12:20
Víctor es el rey de las hamburguesas y pretende ganar la competición.

55:04
Cambia el futuro comiendo mejor

41:04
La cuillère d'or : le concours fait que pour les femmes

41:04
L'Escale | Le plus grand relais routier de France

10:47
Después de los kebabs, ataca al líder de tacos

13:40
Babka, la nouvelle brioche tendance

11:46
El Pabellón Ledoyen y su curiosa y exigente barriga

13:35
Cómo la cápsula de café inundó el mercado

41:15
Qui fera le meilleur dessert ? | Championnat de France du Dessert

51:59
La nourriture du futur : des clones dans nos assiettes

26:41
Cuisine : le coeur de la maison

52:31
Cuisine chinoise : buffets bas de gamme ou meilleure cuisine au monde ?

51:32
Noix de coco le fruit du paradis ? Enquête sur le fruit des Tropiques !

01:11:53
Faut-il arrêter de manger les animaux ?

11:34
Star Meal, el rey de la ensalada industrial

56:58
Restaurants routiers : une tradition française en danger

12:50
La Croissanterie, entre bastidores de una historia de éxito

27:58
Chips de légumes : la révolution ?

25:42
Moutarde de Dijon : que se cache-t-il derrière les étiquettes ?

23:28
Pique-nique : les dessous du panier

27:10
Salon du chocolat : Le meilleur du cacao

51:04
Les secrets des champignons

10:04
Attention aux faux labels et produits du terroir

10:54
Una hamburguesería como ninguna otra.

22:28
Guides et avis : La terreur des restaurateurs

13:56
Glaces : à la recherche du parfum ultime

11:37
Championnat de France : Un Chef Sushi sans préparation

52:00
"Kebab-conomie" : Rentabilité à chaque croc

06:33
Produce mangos marfileños en masa para Europa

09:13
Fiesta en alta mar: un desafío culinario

25:23
Le Saint-Nectaire, difficile de ne pas craquer !

08:12
Il ouvre une crêperie à Sydney et ça cartonne !

11:48
El restaurante de la recuperación y el ingenio

08:08
¿Quién ganará su plaza para la French Burger Cup?

01:51:56
Santé ou profit ? L'envers du décor de l'industrie alimentaire

01:52:10
La réalité du marché laitier

01:55:36
La ilusión de la elección: frutas y verduras estandarizadas

08:13
Mickael, el carnicero emblemático del mercado de Arlés

40:19
Au marché d’Ajaccio, la Corse se dévoile

08:34
Vino caliente, chocolate, gofres... el mercado navideño de Estrasburgo

05:37
El mercado de Estrasburgo, una Navidad XXL

04:55:31
Défis de Chefs Étoilés | Quand la Perfection Devient Une Obsession

26:13
Le Road trip gourmand de Vivien

15:28
L'incontournable dessert des fêtes, c'est bien elle !

04:20:03
L’Art de la gastronomie | Découvrez les meilleurs chefs en compétition

03:22:40
Viandes d'exception, chapons et jambon Ibérique : Les artisans à l'honneur

03:09:27
Chocolat Bonnat, Patrick Roger, Georges Larnicol : Immersion dans l’Artisanat Gourmand 🍰

05:41
Un repas de Noël en deux heures chrono !

04:32:38
Buffets, Brasseries et Restaurants Étoilés : L’Incroyable voyage Gastronomique

26:35
Episode 2 : Le Road trip gourmand de Vivien

04:17
Comment faire du bon foie gras ? Tout est là !

55:07
Poulet fermier VS industriel : Ce qui se cache dans vos assiettes

50:54
Plats industriels | Comment les restaurants vous trompent

30:11
À la recherche du café parfait | L' art de révéler l'âme du café

39:49
Brasserie Georges : immersion dans la plus grande brasserie de France 🍽️

01:28:42
Ce qu’on met dans l’assiette dit qui l’on est | Histoire d'une alimentation engagée

27:50
Hamburguesa, pizza, kebab: comida callejera con un toque lionés

40:23
Brasseries Lipp, una leyenda viva

40:35
Barbacoas, planchas y fogatas: ¡es primavera!

45:09
Familias legendarias | Bocuse-Bernarcon: la gastronomía como patrimonio

28:56
Bosuse d'or, los secretos de la victoria francesa

27:40
La passion plus forte que le handicap : des chefs hors normes

27:50
Brasserie 2.0 : jeunes, rôtissoire et feu sacré

40:32
Ils ont tout quitté pour cuisiner en liberté dans les Pouilles

45:15
Famille Bras, les chefs de l'Aubrac

41:54
Salon du Chocolat : plus chaud que Top Chef

40:44
Le chocolat, tout un art

40:10
Chocolate de alta gama: Los secretos de los maestros chocolateros

28:17
A La Mère de Famille : La plus ancienne chocolaterie de Paris

45:15
Saulieu, Loiseau, et la mémoire d’un géant de la cuisine

25:46
Le Petit Bouillon Pharamond: un restaurante como el de la abuela

41:00
Les chefs contre attaquent

45:14
Nationale 7 | Les Maisons de Famille, et plats de légende sont encore là

41:23
SIRHA 2025 : le salon des chefs

21:42
Desserts extraordinaires, un business sucré salé

30:14
Sous les halles, le terroir se met en scène

02:17:52
Date effacée, odeur masquée, crevettes dans la baignoire, bon appétit !

01:04:16
Viande contaminée : Retour et révélations sur un scandale étouffé

33:17
Ils vivent en ville… et récoltent des kilos de légumes

52:05
Les secrets de la cuisine libanaise de Beyrouth à Paris

02:35:50
15 restaurants testés à Paris, le faux fait maison triomphe

51:08
Wok, flammes et tradition : les gestes secrets des cuisiniers chinois

33:12
L’école des desserts les plus beaux de France

33:06
Fruits et légumes | La filière du Grand Gaspillage

52:10
Terrinas y patés | Los últimos auténticos carniceros de la resistencia

51:44
Crema Fatal | El látigo nunca perdona

32:22
Surpêche | La guerre du poisson a commencé

28:34
Label Rouge: la baguette excepcional en Francia

30:53
McDo, KFC, Burger King | Le scandale Des déchets non recyclable

22:19
Crêpe Mania : Le Fast Food Qui Bat les Burgers à Plate Couture

52:01
Vins natures, vins vivants... rencontre avec des vignerons passionnés

49:54
Saveurs du Maroc | Une Cuisine Ancestrale qui Traverse les Générations

29:44
Crise du blé | Pourquoi le prix de la baguette va doubler ?

50:08
Las verduras eran mejores antes

02:58:46
Fraises, pommes et trésors exotiques : nouveaux goûts, nouveaux enjeux

01:28:04
Les secrets des fastfoods préférés des Français

52:02
Compléments alimentaires : Attention pilule difficile à avaler

27:07
Secrets et Renouveau à la Tour d’Argent : Tradition et Innovation

40:20
Voyage gourmet : Oriental Express et saveurs thaï

01:12:17
El lobby del azúcar se enfrenta a sus víctimas

57:25
El mundo de los cazadores de especias

42:02
Pizza, pression et larmes : l'équipe de France des pizzaïoli

25:24
Machines à pain ou Thermomix : qui fait le meilleur pain ?

51:49
Derrière le moelleux : les secrets du pain de mie

28:32
Steak house : au paradis de la viande

37:58
Bistrot, boulangerie, pâtisserie : les Français à la conquête de NYC

49:48
Comedores y hospitales: ¿qué comemos realmente?

24:22
Viande | Élevage sous Hormones , l'enquête CHOC !

33:51
Pesticides : Manger sain, est-ce encore possible ?

27:12
Los caminos secretos del cerdo

50:21
Pizza, Mozzarella, lo que no dice la etiqueta

01:27:48
Marchés : Arnaques à grande échelle ?

43:17
Quand nos assiettes deviennent mortelles

26:12
HALAL en France: révélations sur un marché opaque

39:30
Food Story : La bataille de foodtrucks

45:13
GASTRONOMIE : la folie des PÂTES

55:16
TRUITE DE BANCA et JAMBON QUINTOA : secrets de terroir BASQUE

29:39
TACOS | La bataille pour devenir numéro 1

01:38:49
LE VOYAGE CULINAIRE de Vivien en Chine

43:25
Meilleur BURGER de France : qui remportera le titre ?

52:05
Vache qui rit : 100 ans d’histoire et de marketing

30:28
PASSION CUISINE JUNIOR

50:16
Truite fumée, fraîche ou sauvage : que mange-t-on vraiment ?

14:01
Street food : la folie du hot dog

51:33
Quand les labels écologiques trompent le consommateur

52:31
Election Miss Blonde d'Aquitaine et Mister Baudet du Poitou

40:00
Hong Kong, Nouvel l’Eldorado de la Gastronomie

24:28
Ces Belges qui veulent changer notre façon de consommer

01:05:34
LE VENTRE DE PARIS

01:09:31
Du Bistrot au Palace : PARIS Capitale Mondiale de la Gastronomie

14:29
7 000 fromages par semaine : l’incroyable succès de Marie

51:21
Cargill : Le scandale alimentaire dont personne ne parle

50:01
Light, zéro, naturel : la grande illusion du sucre

52:32
Cincuenta Sombras de Rosado

25:16
Noël : Champagnes et caviars vraie ou fausse origine ?

30:09
Raclette : Le fromage qui fait fondre toute la France

45:13
SAVOIE : L'extraordinaire hôtel Les Cornettes

02:48
L'ancienne cave à vin transformée en salle de prière

01:49:24
LAIT CRU MENACÉ, FROMAGES EN DANGER

02:31
Il investit 2 millions d'€ pour une technologie unique en France ! 😋

26:45
Bûches, dans les secrets des grands pâtissiers

02:11
Les coulisses de l'usine Sodexo

59:45
Bonbons d'antan, recettes secrètes !

51:45
L'Oignon fait la force

54:41
Arts de la table : la relève

29:49
Ces plantes qui nous soignent

31:01
CHASSEURS DE FRUITS : La quête des SAVEURS perdues

02:40
Des planches apéro haut de gamme ! 🍇🧀

29:51
Comme un parfum d'Italie

32:26
CHARCUTERIE : La REVANCHE d'un MÉTIER d'élite

29:57
PÂTISSERIE : La REVOLUTION des FEMMES chefs

02:23
En caméra cachée il avoue que son produit a une très mauvaise image aux USA

24:04
LA VIE D'APRÈS : Leur success story après la téléréalité

02:53
L'industrie a inventé un poulet ultra performant pour casser les prix

51:35
Cocina india, en todas sus formas

14:10
KOUIGN-AMANN : Du Sucre, du beurre et un gâteau mythique

27:57
Pourquoi ces yaourts bretons s'arrachent à prix d'or

28:20
TRADITION : L'art de la galette des rois parfaite

45:53
La meilleure PIZZA de France ? (Le duel final)

35:05
CÈPES & MORILLES : Le business de l'or blanc en France

25:05
BOULANGERIE : L'automate va-t-il remplacer l'artisan ?

01:52
Le distributeur à pain pour les petits villages

29:34
DÉTOX : Le grand bluff du bien-être

59:17
Los aventureros del cacao perdido

27:31
Les rois de la baguette Low Cost

12:49
100 TONNES D'INVENDUS : Le business secret qui transforme vos déchets en or

52:13
Les maîtres des saveurs - Occitanie

51:30
Bourgogne : Le secret des chefs venus du Soleil Levant

52:09
Leurs cœurs sont grecs ou japonais, mais leur cuisine est parisienne

01:52
La FFA : Fédération Française de l'Apéro 🍷🧀 #food #artculinaire #cuisine

52:13
SAVEURS CORSES : Brebis, Veau bio, safran et huîtres

52:04
Les produits d'exception des Alpes françaises

30:16
THÉ : Les routes de l'or vert

52:01
VIGNERONS: Le défi du vin nature

51:34
ALIMENTATION : Le POISON caché dans nos aliments

49:57
PÂTE À TARTINER : Les secrets de vos POTS préférés

51:57
Les nouveaux maîtres du Grand Est

51:30
GUIDES CULINAIRES : La vérité sur TripAdvisor et le Michelin

24:38
Comment reconnaître une vraie friterie de qualité ?

01:29:19
Baguette de l'Élysée : Les secrets d'Anthony, le boulanger du Président.

42:44
A la recherche de la meilleure Friterie - Province de Liège

45:04
A la recherche de la meilleure Friterie - Brabant Wallon

52:25
BIO : J'ai vu comment les supermarchés vous font payer 150% de plus.

50:54
RESTAURANT : Comment repérer les fraudes au "Fait Maison"

27:25
Les pieds dans le plat | La "police des assiettes" 🇧🇪

28:35
Les pieds dans le plat | L'horreur des cuisines non conformes 🇧🇪

42:49
A la recherche de la meilleure Friterie - Hainaut 🇧🇪🍟🏆

34:41
Faux vins : Comment un faussaire a gagné 36 millions de dollars

51:37
Les petits secrets du roi du poulet

33:49
PARMESAN ET CAMEMBERT : Pourquoi les Américains copient nos meilleurs fromages ?

01:58:18
LOÏC FOU DE CUISINE - 10 RECETTES ICONIQUES ET FACILES

51:13
POIDS DES ALIMENTS : LA GRANDE ARNAQUE

52:08
Un appétit… croissant !

51:45
80% D'IMPORTATION : Le scandale du faux MIEL en France

24:58
SPRITZMANIA : Le secret de la boisson Orange qui a détrôné le MOJITO

01:56:21
La vraie carbonara et le secret du Risotto: Loïc nous régale

31:06